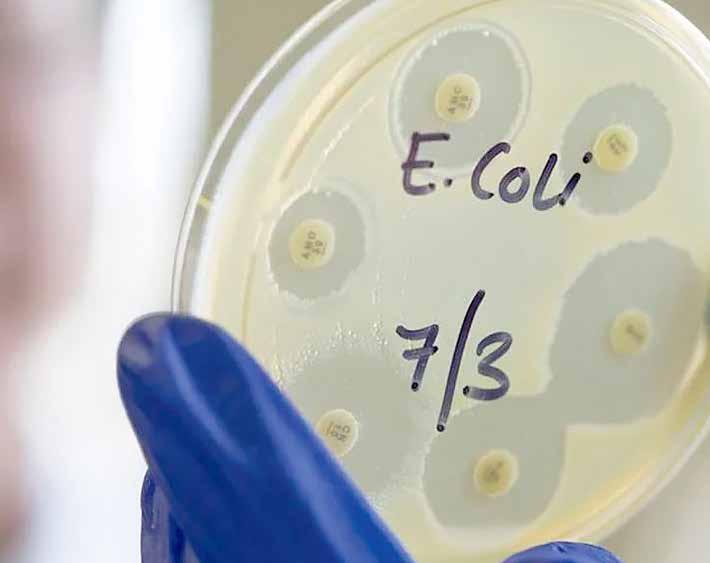

The need for absolute clarity and impartiality when it comes to administering laws in the TCI for TCIslanders was highlighted by Appointed Member Hon Alvin Garland in the House of Assembly. Garland commended the Governor for standing firm, acknowledged the importance of the legal process and also called for fairness across the board, especially for locals, who may unintentionally find themselves in possession of ammunition





As TCI braces for an overly active hurricane season, Deputy Premier and Minister of Physical Planning and Infrastructure Development, Hon Jamell Robinson has unveiled the government’s ongoing comprehensive actions to ensure the safety and well-being of residents and visitors.
Speaking at a press conference on Thursday, June 6, Robinson outlined a multi-pronged strategy encompassing infrastructure strengthening, emergency response coordination, resource allocation, and long-term sustainable planning.
He emphasised the critical role of both governmental action and individual responsibility in ensuring the Turks and Caicos Islands weather the impending hurricane season with unwavering strength and emerge even more resilient.
The theme of the 2024 Hurricane Season, “Proactive Resilience: Thriving Through the Hurricane Season with Preparation and Vigilance,” underscores the government’s commitment to mitigating risks and ensuring community resilience.
During his State of Preparedness address, Robinson highlighted key initiatives undertaken by the government, including significant investments in infrastructure strengthening.
He said: “We are reinforcing critical infrastructure in the event of severe weather conditions this includes upgrading drainage systems and ensuring our road networks remain operational and securing public facilities such as our schools, clinics and office buildings is paramount to ensure

the safety of our citizens and continuity of essential services.
Robinson explained that the Estate Management Department, in collaboration with other government bodies, has formulated robust plans for safeguarding critical infrastructure and facilitating rapid response and assessments,
Recognising the importance of effective emergency response, disaster management teams have undergone rigorous training and are equipped to handle any crisis.
He added: “Emergency Response Coordination, or disaster management teams have been rigorously trained and equipped to respond swiftly and efficiently.
“We have established clear communication channels and coordination mechanisms with local, regional and international agencies to ensure a hopefully seamless response.
Robinson said the government has also allocated resources for

Published by Turks & Caicos News Company Ltd.
Cheshire House, Leeward Highway, Providenciales P.O. Box 52, Turks & Caicos Islands, BWI W. Blythe Duncanson - Publisher/Editor-in-Chief
Faizool Deo - Sports Editor (At Large) Cord Lowe - Graphics Consultant (At Large)
Email: (Advertising) tcnews@tciway.tc, (News) tcweeklynews@gmail.com
Tel. 649-946-4664 (office), 649-232-3508 (after hours)
Website address: www.tcweeklynews.com
Follow us on:
Facebook: facebook.com/tcweeklynews
Twitter: twitter.com/tcweeklynews1
Instagram: @tcweeklynews1
stockpiling essential supplies such as food, water, medical kits, and emergency shelters.
“We have allocated additional funding to ensure the necessary upgrades to shelters across the islands are met.”
In addition to immediate preparedness, the government is integrating long-term sustainable planning into its development strategies. This includes adopting practices that promote resilience, preserving natural buffers, and advancing climate adaptation measures.
While acknowledging the uncontrollable nature of natural forces, Robinson emphasized the importance of personal responsibility in preparedness. He urged all citizens to stay informed, create emergency plans, and actively support community efforts.
“So we are in the strategic planning standpoint…while we cannot control the forces of nature. We can control how you prepare and respond, it is essential that each one of us take personal responsibility for our preparedness, and say that again, it’s important and each one of us takes personal responsibility.
“I urge every citizen to stay ready and create emergency plans and support community efforts and please stay off the government roads when it is flooded.”
Robinson expressed confidence that by embracing proactive resilience and remaining vigilant, the community can navigate the challenges ahead and bounce back quickly from any storm.

A flood warning was in effect for the Turks and Caicos Islands, as heavy rainfall inundated some low-lying, flood-prone areas earlier this week.
Drivers were urged to exercise caution on wet roads and avoid driving or walking through floodwaters that are moving or deeper than four inches.
On Wednesday, June 5, 2024, the National Weather Service identified several vulnerable areas across islands including Providenciales, Middle Caicos, North Caicos, Grand Turk, and South Caicos and advised residents of these areas to be vigilant and take necessary
precautions as prolonged rainfall triggered localised floods.
Adding to the weather woes, a severe thunderstorm warning was issued for the Turks and Caicos and its adjacent waters, effective from 11:30 am to 1:30 pm on Wednesday.
The warning came as clusters of showers and embedded thunderstorms, associated with troughing and interacting with tropical moisture, moved across the region.
According to the Bahamas Department of Meteorology, these storms had the potential to
become severe, bringing squally conditions, dangerous lightning, heavy downpours, hail, and waterspout activity.
Boaters were advised to seek safe harbour, and residents to stay indoors and away from windows during severe weather. Seeking shelter under trees or in water is strongly discouraged, as these can become lightning conductors.
Residents were urged to stay informed about weather updates and follow official instructions to ensure their safety amidst these severe weather conditions. (Olivia Rose)
The recent arrests of several US citizens and subsequent rulings in the Turks and Caicos Islands for firearm possession have sparked concerns among the public and Members of the Parliament, prompting discussions in the House of Assembly regarding the nation’s strict firearm laws and the application of exceptional circumstances in these cases.
During a recent House of Assembly sitting, the Opposition’s Appointed Member Hon Alvin Garland raised the issue during his two-minute speech, highlighting the arrest of five American citizens over the past six months for firearm possession while vacationing in the country
He called on the House of Assembly to clarify the intention of the 2022 amendment to the territory’s firearm ordinance.
He acknowledged the public’s concern and commended the leadership of the governor and the government in handling the situation, given the implications for the territory’s tourism sector.
Garland also referenced communication between the US and Turks and Caicos governments regarding the arrests and the visit of a US delegation to discuss concerns about the detained US citizens.
He underscored the importance of following the legal process to secure their release and return to their families in the US.
He said: “We must first allow the process to take place through the federal court system.
“As I’ve stated earlier, the Governor is correct, to not interfere or to be safe sharing with the judicial process.
“The doctrine of the separation

Opposition’s Appointed Member Hon Alvin Garland
of powers must be upheld and followed at all times.”
Garland explained the role of the three branches of government in the Turks and Caicos Islands, emphasising the separation of powers and the responsibility of the judiciary in overseeing laws and sentencing offenders.
He detailed the country’s history of implementing stringent firearm laws, including mandatory minimum sentences of imprisonment, in response to the increase in firearm-related offenses and murders.
The laws were amended in 2010, 2018, and 2022 to increase the mandatory minimum sentence, making firearm offenses indictable only.

Governor’s Appointed
The amendments also introduced the concept of “exceptional circumstances” to allow for flexibility in sentencing, considering factors such as the offender’s previous convictions and the public interest.
He emphasised the distinction between finding exceptional circumstances and the subsequent sentencing, highlighting the judge’s discretion in determining the length of imprisonment and the size of the fine based on the specific circumstances of each case.
Garland shared his personal experience representing a client who was arrested on similar charges in December 2023.
Police have charged 29-yearold Kerly Agenor, of Dock Yard, Providenciales, with the murder of Butler Brave Prophete.
Agenor is also charged with possession of a firearm, possession of ammunition, discharge of a firearm and discharge of ammunition.
The charges were filed on Thursday, June 6, following advice from the Office of the Director of Public Prosecutions.
Agenor is accused to killing Prophete on March 5, in
Providenciales, contrary to Section 3 of the Offenses against the Person Ordinance Chapter 3.08.
At the time of his death, the 22-year-old deceased victim, a former resident of Wheeland, Providenciales, was exiting his workplace on the Lower Bight when he was fatally shot.
Agenor is remanded to His Majesty’s Prison, and is expected to return to court soon for a Sufficiency Hearing in the Supreme Court, In a brief statement,
Superintendent in charge of Crime, Safeguarding, Public Protection, and Intelligence Dean Holden said: “I wish to thank the officers of the Serious Crime Unit for their dedication and commitment in bringing this case to a charge.
“Further, I wish to reassure the public and families that the RTCIPF is committed to bringing prosecutions against perpetrators and, when possible, closure to persons who have lost loved ones to these senseless homicides.”
to address this issue and ensure fairness, particularly for Turks and Caicos Islanders who may unintentionally find themselves in possession of ammunition.
He called on the House of Assembly to clarify the intention of Parliament in passing the 2022 amendment, opining that the original intent was to allow judges the discretion to impose non-custodial sentences when exceptional circumstances are found.
“I believe this is a very narrow issue… this honourable house does have the responsibility and the power to make a correction or make it clear as to what the intention of Parliament was when they had passed the 2022 ordinance.”
Coupled with this, the Government’s Appointed Member Hon Willin Belliard also spoke on the matter, defending the Turks and Caicos Islands against unfair criticism and emphasising the importance of upholding the rule of law and democratic institutions.
Witnessing the impact of the arrests on the families involved, he stressed the importance of allowing the legal process to unfold and expressed confidence in the attorneys representing the American tourists to make persuasive arguments for exceptional circumstances during sentencing.
However, he also acknowledged a drawback from a recent Court of Appeal ruling, which mandates a custodial sentence combined with a fine even when exceptional circumstances are found, limiting the judge’s discretion to impose non-custodial sentences.
Garland concluded by highlighting the need for a solution
He commended the executive, the Governor, the Premier, the Commissioner of Police, and others for standing their ground and defending the principles of the rule of law. Belliard stressed the importance of allowing the judicial process to take its course and expressed surprise at the approach taken by some, suggesting that it deviated from established legal procedures.
He emphasised the need for the court to make a finding and issue a sentence before further action can be taken, such as issuing a pardon. Belliard concluded by calling for wisdom and understanding, acknowledging the complexity of the situation and the need for a fair resolution.


Calls are being made from sections of society to make clear amendments to the firearm law, so it can remain impartial and practical in its applications.
These calls are not just political plays but are also stemming from the judicial system. Last week, Premier Hon Washington Missick said that “justice has been served as the law intended”. And, many can argue that due to the nature of the cases, it has. However, many TCIslanders believe that “our locals” get the short end of the stick and that justice is selective. They say interpretations can vary, and clearly defined guidelines are needed. Is it time to make needed amendments? Or should it be left to judicial interpretation? What are your thoughts?
Not just in TCI - but in all countries -justice is not blind to money, position, class, status and other subjective considerations. That is a reality of human existence - so, look at Donald Trump’s misbehaviour (do you think an ordinary citizen would be allowed that much latitude?) So, TCI is just a reflection of a wider phenomenon and reality.
He who pays the piper.......
This is not judicious. We need a clear law: people must be able to clearly understand what criminal activity is.
or punishment goes
It is unfathomable how a Premier and “socalled” leader of his people could, in light of what took place, utter that this was how the ‘law was intended’. What any objective observer, devoid of partisan leanings, would observe, this was not justice and justice really and truly only applies to the “thems” and the “Not us” in the TCI.
Justice was tried, exposed and laid flat out for what it really is in this country. What we saw was “red-hot Euro-American imperialism” on display in the TCI. US senators joined in a litany of attacks on the government, people and country, in a manner that was downright insulting. One would have expected the Premier and his ministers to have taken a different position and reaction to those unfounded attacks on the integrity of the TCI. Instead many believe, that the judiciary took cues and suggestions from the government to let those Americans go.
This is against the history where local TCIs had the “books, the entire library,” thrown at them for similar offences. In 2018, the law was amended to provide for exceptional circumstances so that where there was no intent to commit the offence, there was no track record of similar offences, the court in sentencing could consider these exceptional circumstances. Then in 2022, they came back with a mandatory sentencing regime that seemed to “tie judges” hands when it comes to situations where the accused was completely innocent in terms of just not
knowing there was ammunition but doing some time seemed to be the law. Then in 2023, the law seemed to go back to exceptional circumstances. All of this policy and legislative ‘rigmarole’ seem to make “no sense” and confusion arose in the TCI on what a judge could do when it came to sentencing for ammunition cases. Justice is on trial here because the record has shown that there is a law for some but not for others. The Premier should be ashamed for taking a bow for a system that seems weaponised against TCIslanders but pliable when it comes to the temporary tourist found in similar circumstances. Reforms to the law are sorely needed.
When the Premier says that “Justice has been served as the law intended”. This cannot be “justice” or “law” but the product of a system where there is “No rule of law” with the hallmarks of a fascist or dictatorial regime. The Legal system in the TCI is tarnished and its reputation as a fair and independent arbiter of the law is at issue. One would hear conspiracy theories that the system is “rigged in favour of the rich and powerful but one could see the underlying premise of these conspiracies being played out “in your face” in the TCI. There is no evidence to presuppose or suggest that the Governor’s Office called the courts or sent a note that those American tourists needed to be let go otherwise the tourism industry would be imperiled.
“This is something one cannot say or think. Furthermore, such a scenario could not be countenanced because a valid complaint could then be made to the Judicial Services Commission to discipline the judge or court official that would be party and compliant to political pressure of this kind. It is then bizarre how the tune suddenly changes. There was a prevailing narrative that persons found with ammunition had to do “some time” no matter what. We have seen situations where persons from the Caribbean and the TCI were given harsh sentences.
The entire legal system in the TCI seems to be on fire and this is something that the Premier seems not to be cognizant of. He has spoken in an area where ministers do not hold any portfolio. Ministers do indeed sit in the cabinet where policies for the courts are made. So they do have some say, directly or indirectly. So when the Premier uttered what appears to be a talking point that “justice has been served as the law intended”- he must not have given adequate thought to it because it is clear that the system is not working properly.
In the past, we had cases where locals were “thrown away” when found with
ammunition on them. The Premier does not seem to be aware of this. TCIslanders have had their lives destroyed for similar offences in the past, the courts let these American tourists go and that’s justice and how the law was intended to work. The other issue that the Ministers need to take note of, is the confused state of the law when it comes to firearms. Some coherency is needed in the body of law so that the powers of courts can be clearly defined when it comes to sentencing in firearms cases.
The Court of Appeal in the TCI took the point that there is a mandatory sentencing regime for firearm ammunition possession and that exceptional circumstances could override this mandatory sentencing regime. It ruled that “where non-custodial sentences were imposed, it was wrong in principle because the judge had no jurisdiction to impose such a sentence. They were therefore unlawful and unduly lenient”. So how can we depart from a ruling of the Supreme Court that there must be a sentence of some nature? It requires a reform of the laws and the system to remove the appearance of unfairness. In the Attorney General’s reference to the Supreme Court, that court was abundantly clear that exceptional circumstances could not replace the requirement for some kind of custodial sentence.
In that Court of Appeal hearing, the AGs reference, a litany of cases and circumstances were highlighted where locals were given custodial sentences for these kinds of offences. The system is really under scrutiny and needs some attention from the public, the PDM, PNP and other stakeholders. We need to know what’s going on here. How could US senators come in, meet the government, and the position is repeated but then the courts rule otherwise and let these people go?
You cannot have two systems of justice for some and not for the rest. This firearms case opens up some of the issues and problems in the system which people by now thought was properly addressed. There are tangible complaints emerging that need to be
The Turks and Caicos Islands have their sights set on victory in the 2024 Condé Nast Traveler Readers’ Choice Awards.
With nominations for Top Island, Top Beach (Grace Bay Beach), and representation from nearly 20 resorts in the Top Resort category, the islands are poised to make a splash.
Experience Turks and Caicos, the territory’s Marketing and Management Organization announced the nominations in a statement on June 5, 2024. Coming off a strong performance in 2023, where they secured the number spot in the Top Islands in The Caribbean and The Atlantic
category, TCI is determined to clinch the #1 position this year.
The call to action comes from Mr Alvin Hegner, co-chair of Experience Turks and Caicos, who urged everyone to cast their votes and support the islands’ bid for recognition.
“This year we aim to be #1 so I am urging everyone to vote,” he said.
“The Turks and Caicos Islands have been performing extraordinarily well this year, surpassing our arrival numbers from 2023 and emerging as the leading premier luxury destination in the Caribbean for this year so far which speaks to our strength and popularity among our market, hence the nomination in the Top
investigated and looked into. It will require a change in the Administration of Justice and Court reforms which are needed. In the TCI in the past, we have had judges who were rogues and took the law into their hands. The bias was patent, open and obvious. Just look at the saga of the late Lloyd Rodney who appeared before judges that had an interest in cases. In those days, there was no Judicial Services Commission so in terms of the rule of law and discipline of judges, the TCI has come a long way. Let it be made abundantly clear that the judges in these firearms cases are not at issue but the system as a whole. There are too many rules that are unwritten and written rules departed from in the flip of a coin. Let the law be reformed and a codified regime imposed so there is clarity and where there is clarity in the law, one may look forward to “fairness”.
If clear laws were the only rationale to consider, then we would have no need for the judicial system. The police upon learning of the crime could have made that decision, according to the law. Countries, including the TCI, are not governed that way. The judicial arm is there to interpret, to try to make sense and to let better judgment prevail.
Many TCIslanders who are creating a ruckus, are taking these events with the Americans personally. And I would admit that it looked like the enormity of the cases could have altered opinions, but in all fairness, these Americans were just dumb, they were not criminals, at least not in the TCI.
Now take your average young TCIslander, who is in jail, because he borrows his friend’s gun to show off for street cred, and then he is caught. This is a different situation. Or is it? This youngster was also dumb.
So, despite me trying to argue against the status quo, it still comes back to judgment and the obvious callousness that our “own” have to deal with.

Island category,” he added.
The Turks and Caicos Islands have enjoyed remarkable success in 2024, with arrival numbers surpassing those of 2023 and solidifying it position as a leading destination in the Caribbean.
The nominations in the Condé
Nast Traveler Readers’ Choice Awards reflect the islands’ growing popularity and appeal among travellers.
Voting for the awards ends on June 30th, and participants are encouraged to vote multiple times to support their favourites.
Links to Vote:
To vote for The Turks and Caicos Islands in the Top Island Category go to: https://bit.ly/3VozhAh
To vote for Grace Bay Beach in the Top Beach Category go to: https://bit.ly/3KkYZiC
TCI artist HezronH has been selected to participate in a highly anticipated ‘Indelible Imprints’ exhibition in Los Angeles this June.
The exhibition - hosted by SaveArtSpace, in collaboration with DCDG & Co., - will see HezronH participating in the gallery component, curated by renowned visual artist and curator Delaney George, with installations launching on June 14.
‘Indelible Imprints’ is a powerful celebration of the indelible marks made by Black individuals throughout American history, from the era of enslavement to contemporary times. The exhibition aims to honour the resilience, spirit, and unapologetic expression of Black culture and its essential role.
HezronH will join an impressive line-up of artists, including Devin Wesley, Jordan McRae, and Roger Erickson, whose works will be featured in public art installations on billboards throughout Los Angeles, beginning June 14.
The gallery exhibition, opening on the same day at Gallery 90220 (918 E 60th Street, Los Angeles, CA 90001), will showcase the works of these artists alongside 18 additional artists.
It will be on view until June 30, providing an opportunity for art enthusiasts and the general public to engage with the vibrant and

Another exceptional piece by the
impactful works that celebrate Black heritage, beauty, and creativity.
Hezron said his participation in ‘Indelible Imprints’ is a significant milestone in his artistic journey.
His work typically reflects a deep connection and a vibrant expression of contemporary Black identity. Through his pieces, Hezron invites viewers to engage with the rich tapestry of Black history and its ongoing influence on the present and future.
Curator Delaney George, a New Orleans-raised visual artist, photographer, director, gallery owner, and co-founder of DCDG & Co., is expected to bring a unique perspective and a deep commitment to amplifying Black voices through the exhibition. This is HezronH’s second time working with SaveArtSpace. He is currently featured in both in-flight magazines for Bahamasair and interCaribbean airlines.



THE 2024 Hurricane Season is officially underway and the Turks and Caicos Islands are facing the challenge head-on, with a focus on preparedness, partnerships, and timely action.
The Turks and Caicos Islands are taking a proactive stance against the 2024 hurricane season, emphasising a comprehensive approach to disaster preparedness.
To this end, government officials, meteorologists, and emergency management personnel gathered at the Governor’s Office on Providenciales for the 2024 hurricane season press briefing and breakfast to underscore the importance of individual readiness, government investment, and public-private partnerships.
Speaking at the briefing on Thursday, June 6, 2024, the Director of Meteorology for the Turks & Caicos Islands Airports Authority and the National Weather Service Dr Holly Hamilton delivered a sobering message, warning that the seasonal forecast predicts an above-normal hurricane season with a potential for 17-25 storms.
She stressed the importance of preparedness regardless of the forecast, as even a single storm can wreak havoc.
She said: “There’s a lot of media around, you know, the seasonal forecast and whether it’s active, very active, not so active, but the key message here is preparation.
“We already know here in Turks and Caicos it does not take a lot of rain for us to experience flooding… certainly these systems can produce the swells that connect our coastlines.
Dr Hamilton also highlighted the often-overlooked dangers of flooding and rip currents, which can occur even without a direct hurricane hit.
“So again, these surf and rip currents show the far-reaching impact of Hurricane even if they don’t make direct landfall.”
Dr Hamilton disclosed that the Weather Service and DDME is also looking to introduce a weekly tropical weather briefing this year, with more frequent updates closer to the peak of the season.
She said: “That would be another avenue to keep the public abreast of what’s happening in the region so that they’re not caught off guard, because we do observe and watch the development of these systems, or the potential development of these systems so they don’t come as a surprise for us.”
Deputy Governor HE Anya Williams echoed the call for vigilance, stating, “We are only as prepared as our citizens are”.
She urged residents to secure insurance policies, stock emergency supplies, and heed advisories from the TCI Weather Service and DDME.
She said: “So it’s important for us to properly prepare our citizens
and residents Visitors also to the country by providing advice to them on what they should be doing to prepare for hurricane season”.
Williams also emphasised the critical role of collaboration between the government and private sectors, particularly utility companies, in ensuring a swift and coordinated response.
“We also have a responsibility to work very closely with the private sector because we know that we have to work with utility companies and water to ensure that they have preparations in place.
“We have to work with various agencies whether it’s the Red Cross, whether its CDEMA and all the agencies, that provide assistance, and so it’s not just about government, it’s about public and private partnerships, and that is what we’re supposed to be working towards”, she added.
Deputy Premier and Minister of Physical Planning and Infrastructure Development with the added responsibility for Disaster Management, Hon Jamell Robinson said the government has committed to bolstering its disaster preparedness through investments in infrastructure and emergency resources.
He said: “The hurricane season is upon us, and with it comes the inevitable reminder of the power and unpredictability of nature.
However, it is through our collective action and obligation to preparedness that we can mitigate
the risks and ensure the resilience of our communities.
“Proactive Resilience embodies our shared ethos and strategic approach. Proactivity in this context means taking deliberate steps ahead of time anticipating the challenges, understanding the risks, and implementing vital measures to safeguard lives, property, and our critical infrastructure.
“Resilience, on the other hand, speaks to our ability to withstand and recover from the impacts of hurricanes. It is about building systems and communities that are not just able to survive but thrive in the face of adversity.”
Robinson said the government has been tirelessly working on enhancing the disaster preparedness framework which encompasses infrastructure strengthening, emergency response coordination, resource allocation, and long-term sustainable planning.
The Minister outlined key initiatives undertaken to enhance disaster preparedness and ensure community resilience and emphasized the government’s commitment to mitigating risks and safeguarding residents.
Officials stressed that individual preparedness is paramount and reminded residents are to download the DDME’s app for real-time updates and to stay informed through the Turks and Caicos Islands National Weather Service’s social media channels and planned weekly tropical weather briefings.
Scientists at the Colorado State University (CSU) have predicted a supercharged and ‘extremely active’ 2024 hurricane season with 23 named storms, of which eleven (11) will be hurricanes and five (5) will be major hurricanes that can potentially impact the Caribbean Region.
The 2024 Atlantic Basin Hurricane Season officially began on Saturday, 01 June 2024, and will end on Saturday, 30 November 2024.
Experts have also advised that the El Niño-Southern Oscillation (ENSO) is transitioning from the El Niño phase experienced in 2023 to a brief neutral phase, then to a La Niña Phase.
The La Niña Phase Forecast is anticipated to be fully in place by September 2024 bringing rain and increased moisture from the La Niña conditions which could supercharge the season.
On the other hand, it is the El Niño phase that suppresses hurricane formation in the Atlantic Basin — since the El Niño generates more wind shear (winds changing winds with direction and height), which in turn suppresses the activity of hurricanes.
With La Niña the effects are the opposite — reduced wind shear, thus assisting hurricane formation and activity.
Thus, the experts are anticipating an above-normal supercharged 2024 hurricane season in the Atlantic Basin.


In a major development, the Turks and Caicos Islands government has initiated the final bidding phase for the highly anticipated redevelopment of the Howard Hamilton International Airport (HHIA) on Providenciales.
This announcement comes as the government issued an Invitation to Tender (ITT) to five shortlisted applicants on Thursday, May 30, 2024.
The redevelopment project, aimed at transforming HHIA into a state-of-the-art travel hub, has attracted significant interest from global firms.
The shortlisted applicants, representing a mix of renowned construction and airport management companies, will now submit their final legal, technical, and financial proposals for the ambitious project.
Key elements of the redevelopment include the construction of a parallel taxiway and a modern passenger terminal designed to accommodate an estimated 2.5 million passengers, reflecting the islands’ growing popularity as a tourist destination.
Minister of Border Control with responsibility for Ports, Hon Arlington Musgrove emphasised the project’s alignment with the government’s vision for resilient and sustainable infrastructure, while also highlighting the unique investment opportunity it presents for the people of the Turks and Caicos Islands.
Commenting on this milestone
in a statement on Thursday, June 6, 2024, Musgrove said: “The HHIA redevelopment project is a priority for the Turks and Caicos Islands Government, aligning with its objective to develop resilient and sustainable infrastructure while fostering new opportunities for inclusive economic and social growth.
“A notable aspect of this project is the investment opportunity it offers to the people of the Turks and Caicos Islands.
“The TCIAA is hard at work in establishing a project-specific investment fund, through which ordinary Turks and Caicos Islanders will have the chance to invest in the project and benefit from dividends over its successful lifetime. I look forward to more intricate details about this investment opportunity being released very soon”, he added.
Coupled with this, a projectspecific investment fund is being established, allowing locals to invest and reap dividends from the project’s success, the TCIAA further disclosed.
As thousands of visitors continue to pour into these shores via the HHIA, the territory’s main airport facility, the government is moving forward with an aggressive timeline, aiming to select a preferred partner by the last quarter of 2024.
In preparation for this partnership, the Turks and Caicos Islands Airports Authority (TCIAA) is proposing a restructuring that includes the creation of a dedicated
PPP Performance and Contract Monitoring Unit.
This unit will be responsible for overseeing the relationship with the chosen partner, ensuring compliance with project obligations, and safeguarding the interests of the TCI.
According to the TCIAA, the successful bidder will be tasked with designing, building, financing, operating, and maintaining the airport.
The shortlisting process began with the issuance of an invitation for prequalification by the Turks and Caicos Islands Airports Authority (TCIAA) on August 15, 2023.
The first stage of the open international procurement process attracted eight prequalification applications.
The following shortlisted applicants are now invited to submit their final bids to

determine a preferred partner in the project; Manchester Airports Holdings Limited, Winward Management Ltd., and BHM Construction International (UK) Ltd; Ferrovial Airports International SE, and Projetech Construction Management and Services Ltd; Aecon International Construction Services Inc., Olympic Construction Ltd., and VINCI Airports SAS; Regis Holdings S.A., HAB Limited, daa International Limited, and Bouygues Batiment International; and Grupo Aeroportuario del Pacifico S.A.B. de C.V., and John Redmond Associates Ltd.
The selection of a preferred bidder will be based on a comprehensive evaluation of tender submissions, considering technical proposals, financial considerations, and adherence to project requirements.
TCI is marketed as a premium/
niche Caribbean tourist destination, with traffic mainly composed of high-yield United States of America inbound tourists.
The TCI also welcomes regularly scheduled flights from London, UK; Toronto, Canada; and the neighbouring Caribbean region and there is still room to increase its touristic hotel offer density, the main driver for air traffic development.
Against this backdrop, the government has stated that the redevelopment and modernization of the Howard Hamilton International Airport is a priority for the country and that it is committed to ensuring that the project is completed on time and within budget.
The redevelopment project is expected to create significant economic benefits for the Turks and Caicos Islands, including job creation and increased tourism.
In military terms, a stronghold is a defensive structure, often hard to access and strategically placed in an elevated position to provide refuge for those in danger. God is described as being a stronghold “for the oppressed … in times of trouble (Psalms 9:9). And 2 Samuel 2:2-3 says, “The Lord is my rock, my fortress, and my deliverer; … He is my stronghold, my refuge, and my savior …from violent men you save me.” However, there are other strongholds. In 2 Corinthians 10:4-5, it says, “For the weapons of our warfare are not of the flesh but have divine power to destroy strongholds. 5 We destroy arguments and every lofty opinion raised against the knowledge of God, and take every thought captive to obey Christ”
Used in this context, a stronghold is a pattern of sinful thinking that is opposed to God and demonically inspired, that dominates a person’s perspective to the point that it shapes and influences their behavior. The mind is a strategic place, and as such, war is waged for control of it. Look at what Romans 8:5-7 says, “For those who live according to the flesh set their minds on the things of the flesh, but those who live according to the Spirit set their minds on the things

Kenyatta Lewis is the pastor of Harvest Bible Chapel, a growing church committed to taking followers of Jesus deeper and going further in their faith. Besides loving, serving, and helping people he has watched the extended Director’s cut of the Lord of the Rings trilogy multiple times.
of the Spirit. 6 For to set the mind on the flesh is death, but to set the mind on the Spirit is life and peace.
7 For the mind that is set on the flesh is hostile to God, for it does not submit to God’s law; indeed, it cannot.”
Mental/spiritual strongholds are difficult to penetrate and defeat. When there is a demonic stronghold in our mind, the enemy uses it as a base of operation to wage war against our soul. It can linger with a person for years, sometimes unknown to them. It was mentioned earlier that strongholds influence our behavior. I will add that it also affects our emotional state. A stronghold (lie) that says “I am unlovable” produces arguments like “No one will ever love me. No one cares about me. No one wants to get to know the real me.” These thoughts produce actions such as withdrawing from social interactions, avoiding
forming close relationships, and exhibiting low self-value. People may also engage in self-sabotaging behaviors, reject positive attention or affection, and even struggle with trust issues. Additionally, they may develop unhealthy coping mechanisms like substance abuse or overworking to distract themselves from feelings of loneliness and rejection.
So, how do you deal with a mental/spiritual stronghold? You make better, truthful arguments. The only place to get better truth is from the Bible. To those thinking they are unlovable, the Bible says God shows his love for us in that while we were still sinners, Christ died for us. (Romans 5:8). The love of God is such that it is freely given in abundant supply regardless of our sins.
Step one, however, is to recognize and admit that you have a stronghold. Step two is to bring it
down by repenting of it. To repent is to turn away from something. It also includes turning towards something. This is where the truth comes in. As you turn away from the lie (I am unlovable), you must turn to the truth (God’s love for me is demonstrated all the time). Knowing the truth is only half the battle; you must believe and act on it. This can be done by memorizing and repeatedly affirming truths like the one above.
This renews a person’s mind and heart. Being part of a community of faith can provide encouragement and support along with tangible expressions of love and care. With the help of the Holy Spirit, you can overcome strongholds and transform your thinking to align with God’s truth. And you can live free. A person freed from the lie that they are unlovable will have healthier relationships, be more trusting of others, care for their soul and body better, show kindness towards others, engage in community, have peace and joy, experience more energy, and make better decisions. The list can go on and on, but you get the picture. Strongholds are not only found in the minds of individuals; they can be in the collective minds of an entire nation.

Please note that all submissions are subject to editing in keeping with defamation laws and newspaper style. Letters should be accompanied by the author’s full name, location and phone number. Names will be withheld if requested. Send letters to tcweeklynews@gmail.com We welcome letters from all
I believe I shared this story before. I failed my first economics class in college. I did not understand the questions clearly. I answered all the questions but they were not related to the questions that the professor asked and so I failed the exam.
I met with the professor a few days later and we reviewed the exam and quite frankly I knew the answers, but I just didn’t understand what exactly he wanted.
We all have assignments whether as a student, an employee, a parent, husband, wife, a child, a pastor, a politician or whatever role you are in.
 BY DREXWELL SEYMOUR
BY DREXWELL SEYMOUR
Drexwell Seymour is a certified public accountant and is the managing partner for HLB TCI. His favourite hobby, however, is writing. He has a personal website, www.drexwellseymour. com, where all of his writings are posted. He also has a YouTube channel where you can find inspirational videos. Drexwell has a BA in Accounting and an MBA in Finance.
Make sure you understand your assignment. Of course, it is a two-way stream, the assignor should also be clear in the assignment so that the assignee understands what is expected.
I believe I have several

assignments and one of my major assignments is writing. Therefore, when I write, I do my best to ensure that the Average Joe understands my writing. I make it very simple, and I have sub captions, so the long writing does not become a deterrent.
If you are given a task in writing to do, make sure you read the requirements line by line and do it repeatedly until you grasp it.
If you are given a task verbally, make sure the task is repeated and understood by you and the
assignor.
If you still do not understand what you are reading or what was told to you verbally, do not be afraid to ask questions. You may think that your question does not make sense but don’t pretend you understand something and waste time. You may think you are the only one who does not understand but you may be surprised to know that others are in the same shoe as you but are also afraid to ask. You can go a long way in life if you ask questions, especially if you do not understand something.
One way to ensure that you understand your assignment is to test yourself or have someone test you. I know some people do not like testing, but testing is a way to prove your understanding of the information.
Sometimes when we do not understand, we are tempted to copy from others. However, that is not the way. What if you copied
the wrong thing, then both of you will be wrong. Furthermore, what if you must explain the information that you copied and you cannot do so.
Sometimes we think if we change the narrative and give a very good or intelligent response, we will pass the assignment. However, if your response is contrary to the assignment, you will still not pass.
I believe everybody has the potential to pass their assignment. If you understand what you are doing, then you can pass your assignment. The key is to find ways to comprehend your tasks which are listed above. Do not talk your way into and out of things. Do not act as if you understand and end up taking hours to complete a project when it could have been done in one hour.
Make sure you understand the assignment.
As the hurricane season approached, heavy, long, and unusual downpours with gale winds began to emanate and the aftermath was consequential, leaving many high-value properties flooded, as unmanageable surface water settled like mini lakes across districts.
The cloudburst dumped cubic metres of water on many roads, blocking vehicle pathways and leaving many drivers stuck. These intensifying flood events have led to unsafe commuting, discomfort and immobility.
And now, many drivers are left stranded. Their vehicles developed engine problems, as they were forced to drive through feet-high water on minor and major roads across Providenciales.
For me, it seems that car owners may have to invest in a new car after the flood water ordeal and this misadventure certainly cropped up at a bad time, when automobile
 BY D MARKIE SPRING
BY D MARKIE SPRING
prices have increased threefold over the past few months when policymakers ruled on newer, more pricey motor vehicles entering the islands.
In addition to the costs to auto owners, flooding practically causes substantial infrastructure damage with immense adverse social environmental and economic ramifications.
The sad news is this kind of flooding occurred many times prior. In fact, after decades the same areas are still affected, as political inertia
continues to prevent overdue road improvements.
While this is not a political campaign, motorists should know that it is lawmakers who are responsible for these setbacks, which are now costing us so much each time there is a downpour.
So I ask, despite the high cost to vehicle owners and the idea that these rainstorms are inevitable in the future, do you think that we will see any changes in this election year? And if there are no changes to the status quo, how should impacted
residents respond to effectively deal with the next flooding of roads?
It is certain that the next torrential rain will affect us in a similar fashion and until the authorities develop and enact a water management policy framework, the challenges and the public’s reaction will remain.
A sustainable drainage system designed to manage surface runoff is a cost-effective approach, which would work. This design will mitigate flood risks and supplement biodiversity and facility value while utilising an integrated approach of a variety of water management techniques.
Also, the TCI can engineer drains to direct surface water to ponds and the ocean. Legislators should know, that this would muddy the ocean; however, ocean waves and tides would eventually settle the sediments deposited into the ocean in a matter of hours.
In the height of the rainy season, when the quality of the water is best, floodwater could be pumped into storage reservoirs strategically situated in districts prone to flooding.
Considering that the TCI is starved of adequate water supply sources, other water harvesting systems, like artificial, closed ponds, can be installed to collect and store run-off water.
This harvested water can be treated and used for irrigation purposes, gardening, and agriculture, especially during prolonged periods of droughts and in construction. More so, this move would help to bridge the water shortage we began to experience in Providenciales recently.
At this juncture, legislators should know that continuous political inertia, regarding rainwater management, would have grave political ramifications.
Grand Turk, the capital of the Turks and Caicos Islands, was once a quiet and close-knit community. Recently, however, the town was jolted awake by an unprecedented series of bomb threats. Though these threats turned out to be hoaxes, they have left residents questioning the safety and security of our airport terminals.
Despite the quick reaction and response by our law enforcement team, these events have also raised questions about the preparedness of our overall national security apparatus. Are they properly equipped to handle threats of this nature or did it demonstrate a need for more cutting-edge tools to safeguard our nation?
This situation has also prompted local officials to review and potentially overhaul our national security strategies to better address such dangers in the future.
Not long ago, when local gang activity first erupted in sporadic violence, many felt that the country was caught off guard which left top-level law enforcement leaders scrambling to put measures in
BY ED FORBES A concerned citizen of Grand Turkplace. Despite efforts to curb this violence, gang activities have escalated, leaving many lives shattered and have undermined our national security.
If we fail to identify, arrest and expose these perpetrators, they could seek to exploit other vulnerabilities, such as online networks, vessels etc, leading to more serious financial losses and disruptions.
To stay ahead of these threats and become more proactive, should our country hire a security analyst if we don’t have one?
This particular individual will be responsible for defining and implementing robust security measures, policies, and controls based on industry best practices, threat assessment etc. We need experts who can monitor network traffic and respond immediately to potential threats with minimal
disruption to commerce.
Although the Turks and Caicos Islands is a British Overseas Territory, and the UK is responsible for our external security, they are not in a position to respond instantly to every call. Therefore, forming strong regional and international security partnerships is crucial.
The recent bomb threats appear to be linked to the current detention of five Americans being held on ammunition charges. If the ammunition was indeed found in carry-on luggage, the US should be more concerned about a potential TSA security breach, which could have had far more serious consequences.
Furthermore, the meeting that was held between US delegates and our local government should have been centred primarily around a joint effort to thoroughly
investigate these bomb threats and expose those responsible.
The attempt by US Representative Guy Reschenthaler to assert pressure on our judicial system and smear the country’s image was unwarranted and his statement should be retracted.
Our relationship with the US has been robust and beneficial, and it’s not only because of our strong economic trading partnership and tourism. This mutually beneficial relationship goes far back, particularly during the Cold War when the US used our land and airspace as a strategic advantage.
To suggest that the Turks and Caicos Islands are now targeting Americans is absurd and baseless.
With tourism playing a vital role in our marketing strategy, from a public relations standpoint, perhaps we could and should do more to debunk any misinformation.
If the world didn’t know about the Turks and Caicos Islands before, they certainly do now.
The recent events and threats may have inadvertently brought more
positive than negative attention to our nation, demonstrating zero tolerance for such acts.
This situation has certainly been a litmus test for our new governor and the Premier, and it underscores the need for more proactive measures.
Hats off to our dedicated airport security team for stepping up their game with identifying and confiscating these illegal items.
As a proud citizen of these beautiful by nature islands, I must say they have passed this first test with flying colours.
Relative to these two matters in question, many have shared similar sentiments, by looking at it from both sides of the coin. Arguably, there is no jubilee in these criminal sentencing that were handed down and there are no winners.
With such a broad spectrum of cases, each with its own unique perspectives, what we do know is a precedent has been set. We are hopeful the magistrate will continue to examine each case independently for the pursuit of more just outcomes.
The Caribbean Region has a rich and well-documented dancing tradition, from La Bomba, Meringue, and Salsa, just to name a few.
In this case, the Turks and Caicos Islands are no different, as these Islands are home to a variety of different dance forms, and traditions, most notably, Junkanoo and Shayshay - dance forms which have been carefully cultivated, and preserved over the course of centuries of lived experience. In a way, these dance forms are recipes which reflect, and reaffirm the rich history of these beautiful by nature Islands through masterful choreography. These dance forms serve as sinews that hold together the fabric that forms the larger part of the cultural tapestry of the Turks and Caicos.
However, it is interesting to notice that, despite the importance of these dance forms in the cultural makeup of the Turks and Caicos, when we think of dancing, we often think of hip hop, and indeed, of the many other forms of dances which have found their way to our shores, such as ballet, and breakdancing.
Of course, globalisation has played an immense role in propelling hip-hop, and breakdancing in the Turks and Caicos Islands, but my task here is to highlight the importance of our dance forms, particularly dance practices like Shay Shay. I am calling for local dance forms to be at the centre of dances, not for the dismissal of other dance forms, as there is something to learn from all of them. At times, we even think of ballet, and indeed I can still remember my sister, cousins, and their friends taking ballet lessons from Miss Arituza’s Dancing Class. Dancing in this case, was not just another important art form, but a means, or rather, a space where young people were able to create, foster, and reaffirm friendships.
 BY STEVEEN ULYSSE
BY STEVEEN ULYSSE
Bio: Steveen Ulysse is researcher and writer with an interest in storytelling, and oral cultural preservation.
However, Junkanoo and Shayshay alike as local dances form part of our cultural identity, our cultural heritage is etched in each step, each drumbeat, each moment spent dancing. As such, they should hold a premier position where dance matters are concerned, to ensure their longevity.
In the Turks and Caicos, when one thinks of dancing, and jubilation within our various communal and social frameworks, one of the first images that comes to mind is our incredibly skilled Junkanoo band, as evidenced through its many performances all over the Islands, particularly at the weekly Fish Fry. However, whilst Junkanoo, and all of its beautiful pageantry play an important role in shaping the cultural landscape of the Turks and Caicos Islands, it must be highlighted that Junkanoo is but only one of the many different dance styles which are scattered about the Islands. Nonetheless, due to Junkanoo’s hypervisibility, long-documented history, from the days of colonialism, and its overall position on the global stage, through its association within West Indian Carnival arena, it, at times, overshadows other dancing traditions of the Turks and Caicos Islands, pushing them further into the margins, almost to a point of erasure, whilst continuing to monopolise the centre.
Thus, the premier position, through its habitual performances at schools, festivals, and other official functions. Layton Lewis wrote an insightful piece on Junkanoo, its history and importance in the Turks and Caicos - The Cultural
Significance of Junkanoo, which I believe is important in understanding Junkanoo in the context of the Turks and Caicos Islands.
However, in the backdrop, there is Shayshay, binding people together through its rhythmic flavours. Yet, what is Shayshay? Unlike Junkanoo, there is no set definition or parameters of what Shayshay is, or what it entails, which is no accident, as Shayshay is an incredibly complex, and emotionally driven dancing experience. As a result, it is difficult to quantify or narrow down what is meant by Shayshay, as such, I will not attempt to define Shayshay. Instead, I invite each reader to think on the word Shayshay and cast their mind to their many memories of the word, and from that, they can draw their own definition. Whilst, I have not provided a working definition, this does not mean that the free nature of Shayshay should suggest that it lacks structure - quite the contrary! The way I see it, Shayshay gives us the room to dance without rigidity, that itself is a structure, a structure to cut loose - Shayshay distorts structures around dance forms, by manifesting outside of these boundaries.
From my experience, Shayshay has always been an intimate experience, it is something you observe at family gatherings, weddings, and birthday celebrations - Shayshay is embedded in the fabric of family life in a way that Junkanoo through all of its cultural importance cannot. This is not to say that Junkanoo is not intimate,
rather, I am saying that Junkanoo enjoys an elevated position, making it difficult to provide the level of intimacy Shayshay can and has provided to many families. When I think of the Turks and Caicos Islands, I think of the value we place on family, kinship, and community, so it is fitting for Shayshay to find freedom with these familiar systems. This means that Shayshay occupies the hearth, and indeed, the heart of the Turks and Caicos Islands in its capacity as a distinct Turks Island dance form that embodies and highlights the spirit of the Turks and Caicos Islands, reflecting the rich histories of these Islands, and its futures.
Shayshay or rather Shayshying plays such a crucial role in the Turks and Caicos Islands that a lot of other dance forms have been labelled as Shayshay, highlighting the power of this dance. Of course, Shayshay has a history which most have found to be controversial, due to the energetic rhythmic motions required to execute this dance. Mr. David Bowen wrote a fascinating and robust article on this history. I strongly recommend giving it a read, to trace the history of this dance, and its persecution as well - Shay Shay and the Dance Culture of the Turks and Caicos Islands. I believe this persecution forced Shayshay to develop as a private dance form in the shadows, reserved for intimate family gatherings, as I have already mentioned.
I remember fond memories of cleaning on Saturday mornings accompanied by rake and scrape music, where the entire household would get into that familiar Shayshay position - you know the one! That sweet position we all know and love, that position which seems to be innate to us all. Getting into the Shayshay position is as natural as breathing, I do not recall ever learning it, but I know exactly what I should do, when I
hear rake and scrape. Perhaps, it is because I have witnessed this at countless family gatherings and picked it up without realising, or because it is truly one of the most liberating dance forms, giving us room to grow, even as the music intensifies, and joy truly becomes unbridled. These moments came without practice, without thinking, simply through wanting to have a good time, and this is how I will always remember Shayshay. I choose to believe that the first person to dance Shayshay really had a lot to be happy for.
This exploration is not to pit Junkanoo against Shayshay, or any of the other Turks and Caicos dance forms, as they are all equal and integral parts of the Turks and Caicos Islands, different pieces of the same puzzle. The point of this exploration is to highlight the dangers of a single story , or in this case, the dangers of a single dance form, and the importance of balance. The Turks and Caicos Islands are growing, and with this growth, culture has a role to play, and we can see this all around us. What we need to do is walk this line with care, to create an equilibrium where we do not sacrifice one dance form for another. Dancing culture, thus its performances form a key part of the Turks and Caicos cultural experience, to be a Turks Islander is to dance, and to understand the importance and power of dancing.
I leave you with this, whether it is Shayshay, Junkanoo, Maypole Dancing, all these dance forms have a role to play in the cultural development of these Islands. I am pleased to see the work which has been done by the department of culture, to ensure these traditions are passed down, but they cannot do it alone - we all need to be involved. So, when you feel the need to Shayshay, get into that familiar position, and set yourself free, dancing is sharing our history.
A modern recruitment portal was recently launched by the government in an effort to simplify and automate the application process for civil service jobs from start to finish.
Deputy Governor, HE Anya Williams made the announcement this week, stating that the portal will feature job advertisements, allow submissions of applications, online shortlisting and send notifications to candidates on the
status of their applications.
“We are pleased to officially launch the Turks and Caicos Islands Government Online Recruitment Portal, careers.gov.tc, which was spearheaded by our new Business Transformation Unit as part of our objective to not only increase access to government vacancies, but to also improve the efficiency of the application process,” Williams said.
She said as the largest employer
in the Turks and Caicos Islands, the government seeks to ensure that there is easy access to posts that exist within the civil service while also streamlining the application process to make it smooth and efficient.
She added: “In the year ahead we will be recruiting a significant number of new and also existing vacant roles.
“We encourage persons to consider seeking employment
in the Turks and Caicos Government, which following the recently implemented Pay and Grading Review, not only offers competitive salaries and well as a generous terminal benefit program, but also provides employees with the opportunity to make a direct meaningful impact on our islands.”
Commending her executive team for their work in delivering the key objective under the Office
of the Deputy Governor, Williams said she looks forward to the positive benefits that it will reap for employment within the public service going forward.
For those interested in applying for jobs within the TCI Civil Service, upon visiting the site they will be prompted to create a user profile that will include the submission of their personal details as well as all requested supporting documents.




Ms Latanya Gardiner took up the position of new senior product development officer in Experience Turks and Caicos, this week and will be responsible for Grand Turk, South Caicos, Salt Cay, Cotton Cay and Lesser Cay.
As senior product development officer, Ms Gardiner will develop new experiences and also expand and enhance existing products within the country.
Among her responsibilities will be the identification, conceptualisation and development of new tourism products across the Turks and Caicos Islands and collaboration with tour operators and other tourism stakeholders to design new tourism products as well as build relationships between businesses to facilitate collaboration to develop tourism products.
Prior to Experience Turks and Caicos, Ms Gardiner worked extensively in the hospitality sector, most recently as the Property Manager for Vacation Rental, Palm Grove Grand Turk where she marketed the vacation rental, and created effective marketing strategies to attract potential guests through various channels, among other duties.
Ms Gardiner is a graduate of Florida International University (FIU) with a Master’s Degree in Hospitality Management and Johnson & Wales University in
Miami, Florida with a Bachelor’s Degree in Hospitality Management, and an Associate’s Degree in Travel & Tourism Management. She is also the founder and President of The New Vision Foundation, a non-profit organisation that was launched in 2023 for to establish an environment for the youth of Grand Turk to reach their full potential.
In welcoming Ms Gardiner to the Experience Turks and Caicos team, Mr Alvin Hegner, co-Chair of Experience Turks and Caicos, said: “Product Development is a crucial aspect of the work of Experience Turks and Caicos. Developing new products, diversifying our product offering and enhancing existing products are necessary to maintain our position as the Premier Luxury Destination in the Caribbean. Ms Gardiner’s role is vital as we continue to promote our multi-island destination to increase visitation and spend. I look forward to Ms. Gardiner’s innovative ideas in the coming months.”
Ms Gardiner said she eager to hit the ground running and make a lasting contribution as part of the Experience Turks and Caicos team. She said: “A true passion for this industry is rare and comes from deep within. Hospitality is not a job, it’s a way of life.”
Ms Gardiner will report to the Product Development Manager, Ms Candesha Mills.



– TCI men urged to know their numbers, prioritise their health
International Men’s Health Week, celebrated from June 10 to 16, aims at encouraging men and boys to prioritise their physical, mental and emotional well-being.
This annual event – which the TCI takes full advantage of to compel men to be more mindful of their own health – is also a time that communities raise awareness about the unique health challenges men face, promoting proactive approaches to maintaining and improving men’s health
The theme for IMHW 2024 is ‘Stronger Together’, emphasising the importance of community, support networks, and collective action in enhancing men’s health outcomes.
In a statement on the upcoming event, the ministry of health noted that by fostering connections and encouraging open conversations about health issues, a supportive environment can be created where men feel empowered to seek help and make healthier choices.
They also suggested a number of key areas of focus, namely, mental health, physical health, preventative care, healthy relationships and work-life balance.
Mental Health: Addressing the stigma around mental health and encouraging men to seek support for issues such as depression, anxiety, and stress.
Physical Health: Promoting regular exercise, a balanced diet, and routine medical check-ups to prevent and manage conditions like heart disease, diabetes, and cancer.
Preventive Care: Highlighting the importance of early detection and prevention strategies, including screenings and vaccinations.
Healthy Relationships: Encouraging men to build and maintain healthy relationships is crucial for emotional and psychological well-being.
Work-Life Balance: Advocating for policies and practices that
support work-life balance and reduce stress and burnout.
In order to help facilitate lifestyle changes in the men of the Turks and Caicos Islands, the ministry has rolled out a slew of activities that men are urged to attend, learn from and develop the healthy habits shared.
On June 14, at the Smart Parking lot in Providenciales there will be a ‘Check your Numbers, know your Status’ campaign.
This is aimed at encouraging individuals to routinely check key health metrics such as blood pressure, cholesterol, and glucose levels to monitor their risk for chronic conditions. The campaign aims to empower individuals to take proactive steps toward early detection and prevention of serious health issues.
On June 15, at Governor’s Beach in Grand Turk the ministry will host a ‘Men in the Galley’ event where men will showcase their culinary skills by preparing healthy and creative dishes.
Aimed at promoting better nutritional habits, the competition highlights the importance of cooking at home and the role of diet in maintaining overall wellbeing. This activity includes physical fitness challenges and health status checks.
On June 17, a Health Matters Radio Programme on RTC Monday will be hosted at 10am, titled ‘Colon Cancer in Men’.
Following up on that radio show, on June 24, another will be hosted, same time and station, titled ‘Kidney Disease in Men’.
Minister of Health and Human Services, Hon Shaun D. Malcolm noted that men’s health is not just a personal issue, it is a community issue.
He said: “When men are healthy, families and communities thrive. Encourage the men in your life to prioritise their health and seek help when needed.”




The Turks and Caicos Islands government recently held its first Public Service Leadership Forum, emphasising a shift from traditional management to innovative leadership.
The forum held on Monday, June 3, 2024, at the Ritz Carlton Hotel on Providenciales, was spearheaded by Deputy Governor and Head of the Public Service, HE Anya Williams and brought together over 200 policymakers and senior executives to strategise for the future.
Speaking at the high-level conference, Williams stressed the importance of leadership in driving transformative change, urging public servants to be leaders who inspire and take responsibility. She highlighted the need for integrity, fairness, and clear communication, fostering an environment that encourages innovation and risktaking.
She said: “The Turks and Caicos Islands is embarking on major transformative change and senior public servants are responsible for leading this change.
“As we work to lead our public service into this new round, we want our senior public servants to be leaders, not managers. Leadership is not about being in charge. It’s about taking responsibility, and inspiring others to achieve a common goal. It’s about creating a vision, building a team and guiding that team. Through challenges to success.
“A great leader leads by example, they demonstrate integrity, fairness, and consistency in their actions, they communicate clearly and listen, actively valuing each team members input by fostering an environment of trust and respect.
“A leader empowers your team to take risks, innovate and to excel. True leadership is not measured by the latest personal achievements, but by the goals and accomplishments of those they lead.
“Leaders must be willing to embrace change and to navigate uncertainty, then be able to pivot when necessary, and to remain resilient in the face of setbacks”, Williams stressed.
She underscored that the forum was designed to inspire to motivate and to provide a reset for all attendees to drive change in public service.
She said: “As senior leaders let us be dynamic, innovative, forward-thinking and adaptive to change. Let us work together to transform our public service to the benefit of our beautiful by nature Turks and Caicos Islands.”
Premier Hon Charles Washington Misick emphasising human capital development as a major plank of his administration.
He drew inspiration from the success of Singapore, advocating for a unique path for the Turks and Caicos Islands, focusing on productivity and innovation.
He said: “If we look around the world today at some of the countries that started out with far
less physical assets, resources, than we have and look at where they are today…look at Singapore, was started as a swamp and today is one of the leading most productive, innovative societies and countries in the world.
Misick acknowledged the government’s significant investment in the public service and pledged continued support. He called for a focus on delivering high-quality service to both domestic and global stakeholders, highlighting the need for efficient internal processes.
He said: “You see the major plank of my administration. Is human capital development.
“At the end of the day, it is also important for us not to forget that we have to deliver for our customers and our customers are those persons who will be separate sectors of society and our stakeholders, domestically and globally and that requires us to focus on internal processes.”
The Premier also touched on the evolving nature of the public service, advocating for a balance between experience and qualifications.
He said: “We want you to give the government a nine for a nine and not a six or a nine because ultimately, somebody is going to be left out, this economy is growing very fast and so is the need to invest in our social development and this government’s doing that, you know, the world tends to focus on GDP, gross national product.
“More and more we’ve been
pivoting towards our Human Development Index and the steps it takes otherwise...”
He stressed the importance of adaptability and a willingness to embrace change, urging public servants to exercise decisionmaking rights responsibly and with integrity.
Misick said: “Public servants in a public sense, have decision rights and they should be allowed to make honest mistakes without being punished.
“And so, in trying to free up the system and then trying to approach things from a different angle, and asking for productivity and independence of thought and and conviction of character. We have to give them the ability to make decision and by so doing make honest mistakes.”
Minda Harts, a celebrated author and influential speaker, best known for her bestsellers “The Memo,” “Right Within,” and the YA book “You Are More Than Magic”, was the keynote speaker of this event.
Harts is a respected voice in advancing women of colour, selfadvocacy, and restoring trust at work.
She is currently an NYU assistant professor, where she helps to shape future leaders and empowers professionals.
Premier Misick alongside Deputy Governor Williams, keynote speaker Ms Harts, CEO of the Cayman Islands Office of the Public Service Mrs Gloria McField-Nixon, and Mr. Tracey Dewitt from the International
Centre for Parliamentary Studies, participated in a panel discussion titled: “In the Leadership Kitchen: Unveiling the Secret for Success”.
The event concluded with a panel discussion led by Permanent Secretary of Finance Athenee Harvey-Basden, Permanent Secretary of the Office of the Deputy Governor Mr Miquel Swann, Director General of Border Force Mr Emilio Seymour, Director of Technology Mr Andre Mills, and Director of Training Ms Sherrill Poitier.
The discussion focused on Finance and Budgeting, Change Management, Talent Management, and Service Delivery.
Coupled with this, public servants who completed via distance learning the “Successful Managers Toolkit” Course facilitated by the International Centre for Parliamentary Studies in the United Kingdom received certificates of completion.
The event was moderated by Ms Julianna Musgrove, Deputy Secretary in the Office of the Deputy Governor, who kept the event energised and the attendees engaged throughout the day.
The forum underscored the government’s commitment to fostering a dynamic, innovative, and forward-thinking public service.
By prioritising leadership development and strategic planning, the Turks and Caicos Islands aims to drive transformative change and deliver exceptional public services.


This week, Southwest Airlines officially announced Turks and Caicos Islands as one of the new routes to The Orlando International Airport (MCO).
The inaugural flight from MCO to the Howard Hamilton International Airport was welcomed with a water cannon salute by TCI Airport Authority’s Fire Department on Tuesday, June 4.
The announcement comes just ahead of the summer season after the airline’s decision to replace its Fort Lauderdale service due to a recent relocation of its Fort
Lauderdale hub to Orlando.
Southwest Airline Manager, Donneike Gardiner said the team is thrilled about their route change from Fort Lauderdale to Orlando:
“With MCO being a mega station for us at Southwest, it increases our passenger’s ability to connect to more cities across our network by approximately 60%.”
She said the airline’s daily passenger traffic is made up of 95% to 98% connections.”
Gardiner shared that their loads are looking promising with the first flight into Providenciales from
The Royal Bank of Canada (RBC) has joined hands with the Ministry of Education, Youth, Sports & Culture in its initiative to stem youth related violence in the country with a $7000 monetary donation this week.
The Reaching the Streets (RTS) Programme, launched in May, aims to empower youths to break free from criminality.
A statement from the ministry on Thursday, June 6, noted that the demonstration of Public Private Partnership by RBC is a key ingredient required to ensure the success and sustainability of the multi sector intervention programme.
The financial contribution will support the rollout of Phase three of the RTS Programme which focuses on implementation and monitoring impact through ‘Zones of Impact’.
The RTS lead facilitator Dr David Burrow has delivered the promised Strategic Implementation
Plan, which proposes a tailored and cross-cutting set of recommendations to tackle youthrelated gun and gang violence.
The Ministry said it is currently undertaking internal reviews of the framework document and thereafter will convene meetings with the multi-sector working group and all stakeholders to share this critical information and solidify next steps.
Minister Rachel Taylor accepted the cheque along with the programme’s facilitators, expressing gratitude for the contribution.
“This support is crucial in expanding the reach and effectiveness of the Reaching the Streets Programme and exemplifies the positive impact that can be achieved when public and private sectors collaborate towards a common goal.”
The initiative, which is geared towards mitigating violence while building the capacity of
Orlando showing a load factor of 97%.
“Our daily flight from MCO to PLS has an estimated time of arrival of 3:05pm and our flight from PLS to MCO has an estimated time of departure of 4:00pm; except for Saturdays where our estimated time of arrival from MCO to PLS is 12:15pm and PLS to MCO has an estimated time of departure of 2:25pm.”
Passengers can now travel from Orlando to several other nonstop routes to sunny destinations like the Turks and Caicos Islands.
Gardiner said while they will miss the direct flight into Fort Lauderdale, the airline is embracing the inevitable change.
“I encourage our local Turks and Caicos passengers to explore the option of connecting to Fort Lauderdale via Orlando as they will have the ability to have two bags fly free at 50lbs while accumulating their Rapid Rewards points that never expire.”
Commenting on the change, Nikeva Ariza, TCIAA’s Manager of Corporate Affairs and Communications said: “We’re
always elated to add new routes to our destination as route development is an essential part of our mandate to provide customer satisfaction and increasing revenue.”
On Tuesday, the first flight had 139 passengers arriving and 88 passengers departing.
While Southwest has moved from Fort Lauderdale to MCO, there are still ways to connect through Orlando, the TCIAA said, adding that they will continue to partner with its stakeholders to develop and promote all of TCI’s airports for more route development.

key stakeholders, was rolled out in a phased approach in May, commencing with phase one of the programme.
This phase brought together key stakeholders from across the country to participate in nationwide consultations.
Phase two brought the stakeholders together once again to conduct a national training and
development session under the direction of Dr Burrows and his team, to strengthen the capacity of all stakeholders involved with youth development and advocacy.
Phase three, which is where the programme is at the moment, will encompass implementation and monitoring impact.
Facilitators will deliver to the core working group a strategic
implementation plan that will guide the next steps to create a ‘Zones of Impact’.
It is the intention of the ministry, in this phase, to efficiently streamline programmes, allowing better-coordinated access to funding and technical support as well as programme monitoring at a national level through the Department of Youth Affairs.



A worthy acknowledgement of a lifetime of dedication and commitment to the ‘Big South’, recently the TCI Airport Authority officially dedicated the South Caicos Airport to a true son of the soil, Honourable Norman B. Saunders Sr.
Hosted at the airport on May 24, the event saw Premier, Hon. C. Washington Misick, Cabinet Members, Senior Government Officials, Hon. Saunders Sr. and his relatives celebrating the momentous occasion.
Open-minded, positive and a man of the people are just a few of the words used to describe Hon. Saunders Sr. by many who spoke at the event, with the general consensus being that Hon. Saunders has made a gigantic mark, not only on the Big South, but on the entire Turks and Caicos
A fisherman, a hunter, and a Preacher are but few of the many accolades associated with his name. Hon. Saunders has undeniably made an indelible mark on the political and business sphere of these islands.
During the ceremony, the Premier delivered congratulatory remarks, highlighting the TCI Airports Authority’s efforts in completing the significant project. He also shared his vision for the overall growth and development of South Caicos, emphasising the new airport as a catalyst for progress.
Premier Misick also shared his recollections of Hon. Saunders Sr. contributions to the aviation industry in TCI, particularly in South Caicos, however, noting that the statesman is known for a lot more than that.
“As one of the founding fathers of the TCI’s 1976 Constitution, where the establishment of bipartisan politics was born, I think just for that seminal endeavour alone, we should be extremely grateful.
“Because it was the beginning of a time when the whole direction in which this country is going, the intimate involvement of its own people in setting its direction was born.
“I believe just for that alone we owe Hon. Saunders a round of applause,” the Premier stated.
As for his contributions to the political and aviation landscape of the family islands, Misick said all will agree that it was above and beyond the call of duty.
Married to Emily Saunders, the couple has four adult children, who were in attendance at the event.
Hon. Saunders also made remarks at the event in his honour.
“Politics can be good or bad, depending on who you are and how you operate with the voters, and all of us who have been in politics, I’m sure, you have people who hate you with a passion… and there are people who love you and they express that to you, and those are the ones who give you the inspiration to continue to fight.
“I entered politics with a desire to do all I could to help my people and my country, and that was the motto I held throughout my entire period of time in the House of Assembly,” the former House member said of his political life.
In 1969, the Legislative Assembly appointed him to tour and examine the development policies of the Bahamas, Cayman Islands, Barbados and Martinique,
and to make recommendations to the government on policies to be adopted in the Turks and Caicos Islands.
Following the tour, in 1970, Hon. Saunders Sr. was appointed to serve as the first Executive Chairman of the Tourist Board until 1976, a position he said he was most proud of.
“I went all around looking at various models of tourism to decide what the model of tourism for the Turks and Caicos Islands would be, and eventually I came up with high-class tourism as what would benefit the Turks and Caicos Islands… so the tourism industry was my baby,” Saunders recalled. He said he is proud to be one of the catalysts of what obtains in the territory at present in terms of the high level of tourism product in the islands.


Aarone Sargent said the government is seeking to build at least five hurricane shelters that could withstand category five storms over the next two years.
Hurricane Dorian highlighted the insufficiency of such facilities as schools, which are usually used as shelters, and prompted officials to say they would construct hurricane-resistant shelters on each island.
This year’s hurricane season is projected to be the most active in years, with the National Oceanic and Atmospheric Administration projecting 17 to 25 storms, eight
to 13 hurricanes, and four to seven major hurricanes.
Mr Sargeant said officials are working with regional partners and the United Kingdom to get funding for “purpose-built shelters”.
He noted that the construction of a shelter in Central Pines, Abaco, is moving “full speed ahead.” The building would be able to withstand category-five storms with winds up to 200 miles per hour. It will be complete by the end of this year, but will be usable this summer in an emergency.
Officials are also set to open a similar building in South Andros.
Officials said 144 hurricane shelters would be available this
hurricane season, and shelter inspections were complete as of May 30.
Alex Storr, chairman of the DRM authority, said the country is ready to handle a strong storm.
“The infrastructure is in place,” he said.
“I can’t say we are ready for a Hurricane Dorian-type storm because nobody could be, but we are ready to tackle whatever comes our way. You can be confident in that.”
The DRM Authority results from a merger between the National Emergency Management Agency (NEMA) and the Disaster Reconstruction Authority (DRA).
The Premier and Minister of Finance has lauded a ratings agency’s affirmation of Bermuda’s economic stability.
David Burt said that Moody’s Investor Service’s confirmation of Bermuda A2 issuer and senior unsecured bond ratings demonstrated the island’s “upward trajectory”.
He added: “This review along with the Standard and Poor’s reaffirming Bermuda’s A+ credit rating in May is another independent validation of this Government’s careful and thoughtful fiscal approach and demonstrates our success in driving economic advancement and development for Bermuda.
“Overall, Moody’s review
reflected positively on Bermuda and the fiscal management approach being taken to shape our country’s direction and indicates that Bermuda’s bonds are of good quality with a low credit or default risk.
“This confirms that there has been no change in rating since the 2020 report.”
The Royal Gazetteshared Moody’s analysis of Bermuda’s economic rating earlier today.
The rating agency determined that despite the tourism sector suffering a massive blow during the Covid-19 pandemic, Bermuda’s domestic product growth has had a strong recovery thanks to public investment and renewable energy projects. (RoyalGazette)
Russia is preparing to deploy aircraft and combat naval vessels to the Caribbean to conduct military exercises in the coming weeks, its first exercises in the Western Hemisphere involving both air and sea activity in five years, a senior administration official told McClatchy and the Miami Herald.
The Biden administration is not expressing concern over the deployment, with the official stating it poses “no direct threat to the United States.” But the administration believes Moscow intends to use the exercises as a “messaging tactic” after President Joe Biden gave Ukraine permission last week to fire U.S.made weapons across its border into Russia to defend its territory.
The official said the
administration expects Moscow will “conduct heightened naval and air activity near the United States” that will likely include port calls by combat naval vessels in Cuba, and possibly Venezuela — two longstanding Russian allies that have seen occasional visits from Russian naval assets in the past two decades. The exercises may also include “aircraft deployments” and flights in the region, the official said.
Administration officials suspect that Cuba approved the Russian port call “at least in part” over an incident last year in which a U.S. nuclear submarine docked at Guantanamo Bay Naval Base, angering the Cubans, a second U.S. official said. Russia has sailed ships into the

Moscow will “conduct heightened naval and air activity near the United States
Western Hemisphere every year from 2013 to 2020, and has sent flights through the region that have violated the airspace of U.S. allies. But the anticipated activity would
be the first coordinated air and sea exercise of its kind since 2019, during the Trump administration, the official noted.
“We expect that, as is predictable,
the Russians will amp up the information space with this, both to make a point and to unsettle us,” the official said. “We’re not particularly concerned. It’s something that they’ve done before. It’s messaging for the Russians.
“This is about Russia showing they are still capable of some level of naval power projection,” the official added. “We should expect more of this activity going forward.”
Moscow did not inform the Biden administration of the maneuvers. “Ships, of course, are observable, so they kind of don’t have to,” the official said. Biden administration officials notified members of Congress of the Russian deployments earlier on Wednesday.
In the months leading up to Kenya’s deployment of police officers to Haiti, President William Ruto has consulted political advisers, security officials and foreign leaders about the high-profile antigang mission.
He also turned to less conventional counsellors: a circle of Christian evangelical pastors close to him and his wife.
The pastors have issued recommendations to Ruto and served as a conduit between Haitian communities and the president, according to interviews with two of the pastors and three Haitian and American evangelical leaders.
Spokespeople for President Ruto and his wife, Rachel, did not respond to requests for comment for this story.
The pastors’ efforts ahead of the deployment, due to begin later this month, have included meetings with Haitians in the United States, as well as evangelical counterparts, U.S. government officials and even Haiti’s most notorious gang leader, Jimmy “Barbecue” Cherizier.
“We believe that we are a tool that God will use to help,” said
Serge Musasilwa, an evangelical pastor in Kenya involved in the initiative. A sociologist by training, Musasilwa said he has worked on conflict resolution in his native Democratic Republic of Congo and several other African countries.
People involved in the initiative say the relationships forged with Haitian communities will help the Kenyan-led multinational force avoid the mistakes of foreign interventions in Haiti in recent decades.
Besides failing to stabilise Haiti, those missions left behind legacies of human rights abuses and disease, most infamously a cholera outbreak believed to have been introduced by Nepali U.N. peacekeepers in 2010.
A U.N.-appointed panel concluded a peacekeepers’ camp was the likely source of the cholera epidemic, which killed about 10,000 Haitians. The U.N. has not accepted legal responsibility.
“The more you’re connected to the population, the more you can format the kind of intervention you’re going to lead,” said Daniel Jean-Louis, the president of the Baptist Haiti Mission, which has

Kenya’s mission to Haiti will be armed with prayers
worked with the Kenyan pastors.
“This is one of the reasons why all the previous missions failed.”
The U.N. has said it left the country relatively stable when a 13-year peacekeeping mission withdrew from Haiti in 2017. A U.N. peacekeeping spokesperson said the mission had worked in close partnership with civil society and community-based organisations to reduce violence and improve municipal governance.
Not everyone is convinced by the Kenyan pastors’ strategy. Evangelicals themselves have a complex history in Haiti, where they have poured resources into humanitarian projects but also faced criticism for ethical scandals, including alleged child trafficking by some missionaries after a devastating 2010 earthquake, and for preaching intolerance of local spiritual practices.
Pierre Espérance, Executive Director of the National Human Rights Defence Network in Haiti, said Kenya should stick to its security mandate, calling the outreach to gang leaders an insult to their victims.
The Bermuda Police Service (BPS) Financial Crime Unit has confiscated over $200,000 as a result of it investigations into money laundering over the last few years.
Since 2021, five individuals have been convicted, leading to the seizure of these illicit funds.
In a statement the BPS said: “These successes were realised thanks to a collaborative effort involving partner agencies, all with a commitment to prosecuting those who violate the law.”
Several additional cases are currently pending in both
the Supreme and Magistrates’ Courts, involving over $400,000 in suspected illegal funds.
Detective Chief Inspector Jason Smith of the Specialist Investigations Unit (SIU) emphasized the BPS’s commitment to tackling financial crimes.
“The BPS remains unwavering in its pursuit of those who choose to engage in criminal activity, and we continue to encourage anyone with information regarding suspected money laundering offences to come forward. Together, we have the power to
make a difference,” he said in the statement.
A spokesperson for the Department of Public Prosecutions praised the detection and prosecution efforts.
“We are pleased with the rate of detection of money laundering offences which have led to successful prosecutions and convictions before the courts,” the spokesperson stated, expressing gratitude to the investigating officers and partner agencies for their contributions to these positive outcomes. (Loopnews)
“It’s not a question of the gospel (or) praying with gangs that will resolve problems,” he told Reuters.
‘FAITH DIPLOMACY’
Ruto and his wife wear their faith very publicly. They have involved evangelical leaders in matters of state, including through the First Lady’s “faith diplomacy” programme, which enlists religious leaders to support social initiatives.
While meeting in March with evangelical pastors at the Weston Hotel in Nairobi, Rachel Ruto dropped by a separate event in the same building and explained the group was working on a “spiritual solution” for Haiti.
“We cannot allow our police to go to Haiti without prayer,” she said, according to video from The Star, a Kenyan newspaper.
The pastors’ close involvement in Haiti policy provides some insight into President Ruto’s commitment to the mission, which has remained unwavering despite repeated delays and vocal opposition from many prominent Kenyans.
Evangelicals have long taken an interest in Haiti due to the magnitude of its humanitarian crisis and concerns about traditional Vodou beliefs that some see as Satanic. Haiti is the least developed country in the Western Hemisphere, according to the U.N., and is facing surging gang violence that killed more than 1,500 people in the first three months of this year.
“I think that first and foremost it’s an expression of their faith,” said Pete Inman, an American businessman and evangelical close to the Rutos. He added there was also a strategic motivation for the mission because it bolstered ties to the U.S., the mission’s main financial backer.
In public remarks, the president has cited a moral responsibility to Haiti’s African-descended population.
Inman said he connected Musasilwa with Fred Eppright, who leads the Haiti Baptist Mission’s U.S. arm, after Ruto announced the mission.
Musasilwa visited Eppright in Austin, Texas late last year and then invited him and several of his colleagues in March to Nairobi, the two men said.
There, over four days at the upscale Weston Hotel, Jean-Louis, Eppright and two other American evangelicals prayed and strategised with four Kenyan pastors before being joined on the last day by Rachel Ruto.
“It was a four-day deep dive into how they would do the involvement,” said Eppright.
The group drafted a white paper that Rachel Ruto presented to her husband a few days later, he said. Jean-Louis said the proposals addressed four topics: law and order, the humanitarian situation, political leadership and a spiritual component.
The next month, Rachel Ruto and three of the pastors travelled to Austin and Miami, where they met with evangelicals, members of the Haitian diaspora and police department leaders.
Haitian diaspora members made proposals to be conveyed to President Ruto, covering everything from legal authority for the mission to its duration, Jean-Louis said. Reuters could not determine whether their recommendations were delivered to the president.
While in the United States, the Kenyan pastors held a Zoom call with Haitian gang leaders, including Barbecue, a former police officer who says he leads an alliance of major gangs called Viv Ansanm.
Musasilwa led the conversation. He declined to go into details, but it left him with hope the conflict could be resolved peacefully, he said.
“This guy might be a devil, but there is something that we can build on,” Musasilwa added.
Reuters was unable to reach Barbecue for comment.
Musasilwa said he has also met with U.S. State Department officials. The State Department declined to comment.
Free National Movement leader Michael Pintard said he does not intend to increase the value-added tax rate above ten per cent if elected prime minister of the Bahamas, despite vowing to remove the tax from certain healthy foods, medicines and feminine and infant care products.
The Minnis administration raised VAT to 12 per cent, insisting this was needed to accomplish its fiscal consolidation plans. The administration simultaneously removed VAT from breadbasket items as a concession.
The Davis administration, in turn, reduced the VAT rate to ten percent but eliminated VAT exemptions. Removing exemptions angered some, especially because the Progressive Liberal Party did not foreshadow this during its election campaign.
This week, Mr Pintard said he does not intend to increase the overall VAT rate to compensate for the potential revenue loss of removing VAT from certain items. He discussed his VAT exemption plan during Saturday’s one-day FNM convention.
He said yesterday: “There are areas that affect the most vulnerable Bahamians, where there is a substantial amount of purchases that are carried out in those areas and we believe that Bahamians need relief in those particular areas and that we should find a way to do that.”

Mr Pintard said other revenuegenerating measures would offset the VAT concessions.
“If you do what you need to do in terms of collecting outstanding revenue, if you do what you need to do in terms of improving the health of Bahamians, you will reduce the amount of money you have to spend to correct the health dilemma that emerges,” he said.
“I believe that if you protect Bahamians on the front end, meaning healthy foods that help them, less chance of them getting
sick, and demanding millions more on the back end for treatment, then that is a good thing.”
Likewise, he said if people can afford medicine, this would reduce the fiscal strain on the government.
“I don’t buy that there’s going to necessarily be some substantial increase or shortfall in revenue,” he said. “The long-term benefit will not only be good for people’s health, but also for us to better manage the scarce resources that we have.” (Tribune242)
Sint Maarten’s hopes to secure mobile generation units from its sister islands to alleviate its electricity woes appears to no longer be a reality, with the government now looking for an alternative way to source these units.
Deputy Prime Minister Veronica Jansen-Webster stated this as she delivered a national address on NV GEBE’s energy crisis after it was recently revealed that the country’s sole electricity provider, NV GEBE, is currently unable to generate the power required to supply everyone.
The Dutch Caribbean Island has been grappling with load shedding with matters being made worse on Sunday, June 2 after GEBE was affected by a fire which rendered two more engines inoperable and resulted in an island wide blackout.
Power was eventually restored to communities with residents immediately returned to the load shedding schedule.
In response to last Sunday’s incident, a crisis team meeting was urgently convened with representatives from the Netherlands, Curacao, Aruba, and St Maarten.
Initially the government believed it could secure sufficient mobile generators from its sister islands. She says regrettably, this
is not the case as the quantities needed to mitigate Sint Maarten’s crisis and halt the relentless load shedding are not available.
The Deputy PM says the government is not deterred, and in collaboration with GEBE’s management, is actively exploring alternative sources to acquire mobile generation units.
She notes a swift, short-term plan is being finalised to ensure these units are delivered and operational as quickly as possible, aiming to restore normalcy to the island.
In the meantime, the public is urged to conserve energy wherever possible.
NV GEBE in a recent statement had identified its ageing power generation units, climate change and the growing economy as reasons for the rapid increase in load demand. It explained the company operates a fleet of 10 traditional power generation units, which are reciprocating diesel engines. Out of these 10 units, three (30 per cent of the total fleet) have exceeded their technical lifespan of 30 years.
The electricity company is expected to host on June 7, a public information series “Candid Conversations with NV GEBE” featuring in depth discussions about NV GEBE’s state of affairs. (Loop News)
police: Investigation ‘still ongoing’ in Detention Centre sex assault claim
Months after a Jamaican woman claimed she was sexually assaulted at the Carmichael Road Detention Centre, police said they are still investigating her allegations.
Chief Superintendent Michael Johnson could not give a timeline when the probe would be completed, telling The Tribune: “It is still ongoing.”
Last December, a 40-year-old Jamaican woman and her 11-yearold son were released from custody after The Tribune contacted immigration officials and people from the Jamaican Consulate in The Bahamas asked about her condition.
The woman said she was sexually assaulted in immigration custody and continually abused after complaining about an officer’s actions.
Since the alleged incident, she said she has made several statements to police –– the most recent last month –– but has not yet heard back from them.
“To me, they just don’t care,” she said. “I am a human. I’m still feeling pain. I just need justice.”
She claimed her alleged assailant continued to harass her by showing up at her home and at court whenever she appeared for an unrelated matter.
“Last week Friday when I went to court, the immigration officer said my life is in danger. He told me he not leaving me. He told me that,” she said. “I am scared.”
She said she could not leave the country because authorities had not returned her or her son’s passports and other personal items.

Scottish Conservative leader Douglas Ross is to stand in the general election.
Mr Ross’s surprise announcement came after the party effectively de-selected David Duguid as the Conservative candidate in Aberdeenshire North and Moray East.
Mr Duguid, who is unwell, was the MP for Banff and Buchan since 2017.
Mr Ross was supposed to be standing down from Westminster
at this election to concentrate on his job as an MSP ahead of the 2026 Holyrood election campaign.
He described Mr Duguid as a “friend and colleague” and said it was with “regret” the party management board decided he could not proceed as the party’s candidate.
Mr Ross told a hastily arranged press conference to announce his intention to stand in Aberdeenshire North and Moray East: “This constituency will be

A World War Two US Navy veteran travelling to France for an event marking the 80th anniversary of the D-Day landings has died, a veteran organisation has confirmed.
Robert “Al” Persichitti from Rochester, New York, was airlifted to a hospital in Germany on 30 May after suffering a medical emergency aboard a ship heading to Europe.
He died the following day, aged 102.
Remembered as a “great, humble man,” Mr Persichitti was involved in the allied operation in Japan.
Honor Flight - a veteran organisation Mr Persichitti belonged to - confirmed his death on social media and said he had “served his country bravely without hesitation”.
The non-profit helps transport former US servicemen to the memorials of the respective wars they fought in.
The 102-year-old was selected to attend the event in Normandy by the National World War Two Museum in New Orleans, which paid for and organised the trip, a local affiliate of CBS News, the
very competitive, a hard fought, close contest between the Scottish Conservatives and the SNP.
“I have decided I need to lead from the front.”
He said he would apply for his party’s nomination on Thursday evening – a matter of hours before the deadline for potential candidates closes at 16:00 on Friday.
The decision to effectively de-select Mr Duguid means he will miss out on a near £15,000 redundancy payment.
MPs who lose their seat or unsuccessfully stand for another seat are given twice the statutory redundancy entitlement as a loss of office payment. Those who do not contest a seat do not receive the payment.
Mr Duguid would have received £14,700 for his seven years as an MP but will no longer be entitled to it.
Mr Ross distanced himself from the decision not to select Mr Duguid, but said the party had made the decision “to prioritise his recovery”.
The Scottish Tory leader had been an MP since unexpectedly defeating SNP Westminster leader Angus Robertson in the 2017 general election.

Douglas Ross had previously announced he would step down at the election
Shortly after becoming Scottish Conservative leader in August 2020, he said he would step down as an MP at the next general election.
He has been an MSP for the Highlands and Islands since 2021.
Mr Ross, who is also a football assistant referee, has been branded “three jobs” by his opponents.
He donates his MSP salary of £72,195 to charity, while the Holyrood register of interests shows he has received more than £6,500 this year from the Scottish Football Association for his role as an assistant referee.
Mr Ross’s former Moray constituency has been abolished under boundary changes at this year’s election. He had opposed the “carve up” of his seat.
Mr Duguid’s former seat, Banff and Buchan, is being expanded
to include parts of Moray and renamed Aberdeenshire North and Moray East.
Mr Duguid said on Wednesday he had been “looking forward” to campaigning but had not been selected to stand in the new Aberdeenshire North and Moray East constituency.
He had recently spent four weeks in the intensive care unit at Aberdeen Royal Infirmary due to an illness affecting his spine. It is understood he is still in hospital.
A spokesman for the Scottish Conservatives said the decision had been made on health grounds. The old Moray constituency is to be cut in two, with Keith and Buckie swallowed up by Aberdeenshire North and Moray East, while Elgin joins a new Moray West, Nairn and Strathspey seat. (BBC)
BBC’s US partner, reported.
“I’m really excited to be going”, he told broadcaster WROC-TV a day before he set off.
His cardiologist had encouraged him to travel, he added.
Al DeCarlo, who served alongside Mr Persichitti in Japan, was also on the trip. He told local media in Rochester that his friend did not die alone.
“The doctor was with him... he was at peace and he was comfortable,” he said, according to ABC news agency affiliate, WHAM-TV.
“She put his favourite singer, Frank Sinatra, on her phone and he peacefully left us.”
The pair served in Iwo Jima together, a Japanese island the US captured from the country’s imperial army in 1945.
Mr Persichitti’s friend of 46 years, Pastor William Leone, told WHAM-TV “he had a real zest for living” and would visit children in local schools to talk to about his experiences.
The veteran was also a former teacher. In April, students at a local school helped organise a birthday celebration in his honour.
Russian President Vladimir Putin has warned that Moscow could arm countries with a view to attacking Western targets.
Mr Putin made the statement while criticising the West’s delivery of long-range weapons to Ukraine.
Several countries including the United States have given Ukraine the green light to strike targets inside Russia.
Such action could lead to “very serious problems”, Mr Putin told foreign reporters.
“If someone thinks it is possible to supply such weapons to a war zone to attack our territory and create problems for us, why don’t we have the right to supply weapons of the same class to regions of the world where there will be strikes on sensitive facilities of those countries?” the Russian president said.
“That is, the response can be asymmetric. We will think about it.”
He did not specify which

countries Moscow could supply weapons to.
Mr Putin singled out Germany, which recently told Ukraine it was free to hit targets inside Russia with long-range German-made weapons.
“When they say that there will be more missiles which will hit targets on Russian territory, this definitively destroys RussianGerman relations,” Mr Putin said.
US President Joe Biden has
given Ukraine permission to use American-supplied weapons to strike targets in Russia, but only near the Kharkiv region. The White House has said Ukraine cannot use long-range ATACMS missiles on Russian soil.
Ukraine has used US weapons to strike inside Russia in recent days, a US senator and a Western official told the Associated Press on Wednesday.
US President Joe Biden’s Republican rivals, and some of his Democratic allies, have criticised his new executive order aimed at curbing record migrant arrivals at the US-Mexico border.
Under the order, which took effect at midnight, officials can quickly remove migrants entering the US illegally without processing their asylum requests.
Left-wing Democrats, activists and the UN have voiced concerns, while Republicans have criticised the plan as an election-year ruse, arguing for tougher action.
But Mr Biden says his Republican opponents stood in the way of a bipartisan border security deal that failed in Congress earlier this year.
Former US President Donald Trump, the Republican candidate in this November’s election, slammed Mr Biden’s executive action on Tuesday.
Mr Biden had “surrendered our southern border”, and was now “pretending to finally do something” about it, Mr Trump wrote on social media. He was echoed by others including Texas Senator Ted Cruz.
The president hit back, accusing the Trump camp of an “extremely cynical political move” by pressurising Republican lawmakers to block the proposed border plan in Congress earlier in the year.
Speaking on Tuesday, the president vowed that his executive order would “help us gain control of our border”.
He asked left-wing critics for their patience. “Doing nothing is

not an option,” he said.
About a dozen advocates and Democratic lawmakers had their own press conference outside the US Capitol on Tuesday, criticising Mr Biden’s decision.
Pramila Jayapal, the chair of the Congressional Progressive Caucus, said she was “profoundly disappointed”, calling the order a “step in the wrong direction”.
More than 6.4 million migrants have been stopped crossing into the US illegally during Mr Biden’s administration. The arrival numbers have plummeted this year, though experts believe that trend is unlikely to continue.
The White House says the new order “will be in effect when high levels of encounters at the southern border exceed our ability to deliver timely consequences, as is the case today.”
The restrictions will come into force when the seven-day average
for daily crossings hits 2,500when the border is “overwhelmed”, as the White House describes it.
“They will make it easier for immigration officers to quickly remove individuals who do not have a legal basis to remain,” officials explained.
The border will reopen to asylum seekers only when the average figure holds at 1,500 over a sevenday period - and it will then reopen to migrants two weeks later.
Other measures are aimed at quickly resolving immigration cases in court, and expedited removals for those found to have no legal basis to remain in the US.
Asylum processing at ports of entry will continue under the order.
About 1,500 asylum seekers go through the process at official crossings each day, mostly after setting up appointments using a Customs and Border Protection (CBP) app known as CBP One.
An appeals court in Georgia has delayed Donald Trump’s election interference trial until it rules on whether Fulton County District Attorney Fani Willis can remain on the case.
Lawyers for the former US president have repeatedly sought to have Ms Willis removed from the case, arguing her romantic relationship with another prosecutor created a conflict.
Last month, the judge overseeing the case said the court found no conflict of interest and allowed the case to proceed, pending Trump’s appeal. But Wednesday’s decision will prevent the case from proceeding until the appeal ruling on Willis.
The Georgia Court of Appeals currently is scheduled to hear arguments on 4 October, making it highly unlikely that the case will be settled ahead of the presidential election in November.
Trump and 18 others are being prosecuted in Georgia for conspiracy to overturn the state’s 2020 election results, which they deny.
The trial was nearly upended after one of the co-defendants claimed that Ms Willis was improperly benefitting from a romantic relationship with lead prosecutor Nathan Wade.
Over several tense days in court in February, Ms Willis admitted she had had a relationship with Mr
Wade, but denied any benefits.
Judge Scott McAfee ultimately found in March that Ms Willis had a “serious lapse in judgment” and that the relationship damaged the case with the “appearance of impropriety”.
But he ruled the case could continue with Ms Willis as long as Mr Wade resigned. Mr Wade stepped down soon after.
The appeals court has until mid-March - months after the next four-year presidential term begins in January - to issue its decision, leaving the case paused until then.
The losing side has the option to appeal the case further to the state’s supreme court.
The Georgia election
- which works with Haitian migrants at the border - called the announcement “a direct assault on the fundamental human right to seek asylum”.
A spokeswoman for the UN’s refugee agency insisted that people fearing persecution must have access to safe territory.
The issue of migration has become a headache for Mr Biden in an election year. Trump has vowed to carry out the “largest deportation operation” in American history to remove undocumented migrants already if he is re-elected.
Among the actions announced were the use of a 1952 law that allows access to the asylum system to be restricted.
The law, known as 212(f), allows a president to “suspend the entry” of foreigners if their arrival is “detrimental to the interests” of the country.
The same regulation was used by the Trump administration to ban immigration and travel from several predominantly Muslim countries and to bar migrants from asylum if they were apprehended crossing into the US illegally, provoking accusations of racism.
“It’s unfortunate that politics are driving the immigration conversation in an increasingly restrictive direction,” commented Jennie Murray, president and the CEO of the National Immigration Forum.
Guerline Jozef, executive director of Haitian Bridge Alliance
Biden administration officials have resisted comparisons with policies from Trump’s presidency, saying the new rules touted on Tuesday would only apply during periods of increased arrivals. They said exemptions would be made for unaccompanied children and those being trafficked.
The Biden administration plans to defend the new policies in court from any legal challenges it could face - a risk that was highlighted by Ms Jayapal.
Mexican media have depicted the move as one of Mr Biden’s toughest policies, though President Andrés Manuel López Obrador sought to downplay the issue, arguing that economic and cultural exchange made a border closure “impossible”.
Authorities in Tijuana asked what would happen to asylum seekers denied entry to the US. Shelters in the Mexican city could quickly get overcrowded, one local official warned. “We’d start seeing people on the streets, sleeping in tents”. (BBC)

The EU has become the second major global economy to cut its lending rate this week, saying it had made progress in tackling inflation.
The European Central Bank (ECB) announced a cut in its main interest rate from an all-time high of 4% to 3.75%.
That follows Canada’s decision on Wednesday to cut its official lending rate.
The ECB’s move comes as voters head to the polls for EUwide elections over the next four days, with the outcome expected to reflect people’s unhappiness over cost-of-living pressures.
Christine Lagarde, president of the ECB said the outlook for inflation had improved “markedly”, paving the way for the rate cut.
However, she warned that inflation was likely to remain above the bank’s 2% target “well into next year”, averaging 2.5% in 2024 and 2.2% in 2025.
The ECB would keep interest rate policy “sufficiently restrictive for as long as necessary” to bring inflation down to the Bank’s 2% target, she said.
However, she added: “We are not pre-committing to a particular rate path.”
Lindsay James, investment strategist at Quilter Investors said the rate cut had been widely anticipated but would nevertheless come as a relief to

consumers and businesses on the continent.
“The ECB has stolen a march on the Bank of England and [US] Federal Reserve – who are both potentially still a few months away from cutting – and will breathe life into an economy that desperately needs some form of stimulus,” she said.
Central banks have kept rates high for the past two years to bear down on the rate at which prices are rising, with most targeting an annual inflation rate of 2%. But higher interest rates tend to dampen
economic growth.
A cut in interest rates should boost economic activity by making it cheaper for consumers and businesses to borrow.
Meeting in Frankfurt on Thursday, the EU’s rate-setting body decided to cut rates, despite a slight uptick in inflation in May. Inflation rose to 2.6%, from 2.4% in April in the 27-nation bloc.
The ECB’s decision followed Canada’s rate cut on Wednesday which brought its headline rate down from 5% to 4.75%, after inflation there fell to 2.7%. Sweden
and Switzerland have also trimmed rates.
Ms Largarde gave a broader assessment of the eurozone’s economic outlook. She said: “Our overall confidence in the path ahead — because we have to be forward looking — has been increasing.”
But she also warned of potential “bumps in the road” ahead for the region.
“The risks to economic growth are balanced in the near term, but remain tilted to the downside over the medium term,” she said, citing conflict in Ukraine and the Middle East.
Geopolitical tensions could weigh on growth, while extreme weather events and the climate crisis more broadly could drive up food prices, she warned.
However, Katherine Neiss, chief European economist at investment firm PGIM said she was “reasonably confident” that the ECB would cut rates further over the summer or autumn, resulting in eurozone rates that were at 3.5% or lower by the end of the year.
“Growth is encouragingly recovering from the recession that the euro area went through towards the end of last year, but it’s still sluggish,” she told the BBC’s Today Programme.
That factor, combined with slowing inflation and easing wage growth, would justify another rate
cut, she said.
UK rates have yet to start coming down, although there is some speculation the Bank of England could trim them as early as this month.
UK inflation has fallen to 2.3%, a long way down from its peak of over 11% in late 2022.
Last month, the International Monetary Fund suggested the Bank of England should cut rates from their current 5.25% to 3.5% by the end of the year.
However, George Godber from Polar Capital said the upcoming election in the UK would “complicate” the Bank of England’s next decision on 20 June.
The Bank is politically independent, but the Conservative government had made falling interest rates part of their promise to voters, which could influence “mindsets”, Mr Godber said.
“If they cut it’ll be political, if they don’t cut it’ll be political,” he said.
The US Federal Reserve is also expected to cut rates in the coming months, although the latest US inflation figure is higher, at 3.4%.
The Fed was likely to make its first move on rates ahead of the immediate run-up to voting in November, Mr Godber said. (BBC)
Some 113 people have become ill with E. coli in recent weeks and experts believe it is most likely linked to a nationally distributed food item.
The UK Health Security Agency says testing of samples suggests all of the cases since 25 May are “part of a single outbreak”.
Based on the wide geographic spread, it is likely a contaminated batch of product that people can buy around the UK.
In December, a person in Scotland died from E. coli linked to cheese.
The source of current outbreak though is not yet confirmed or known. Consumers will be told if there is a food identified.
There is currently no evidence linking the outbreak to other potential E.coli sources such as petting farms, drinking water or swimming in contaminated sea, lakes or rivers, say the officials investigating it.
A number of foods have
carried E.coli before, including beansprouts, pre-packed salads and undercooked meat.
The number affected is expected to rise as more samples from patients get tested.
So far, there have been: 81 cases found in England; 18 in Wales; 13 in Scotland and 1 in Northern Ireland.
The youngest who has become ill is aged two and the oldest aged 79. The majority though have been young adults and some have been in hospital.
Symptoms include severe and sometimes bloody diarrhoea, stomach cramps, vomiting and fever.
It usually takes a few days from being infected for symptoms to show.
Most people recover well, but some - such as young childrencan become very unwell. Call NHS 111 or contact your GP surgery if you are worried.
E. coli are a diverse group
This outbreak is a Shiga toxinproducing E. coli (STEC).
There are things people can do to reduce the risk of infection.
Trish Mannes, Incident Director at UKHSA, said: “Washing your hands with soap and warm water and using disinfectants to clean surfaces will help stop infections from spreading.
“If you are unwell with diarrhoea and vomiting, you should not prepare food for others while unwell and avoid visiting people in hospitals or care homes to avoid passing on the infection in these settings.
“Do not return to work, school or nursery until 48 hours after your symptoms have stopped.”
Alcohol-based hand gels will not stop E. coli.
In March, rowers taking part in the 2024 Boat Race between Oxford and Cambridge in London were told not to enter the Thames after high levels of E. coli were found. (BBC)

IVANNA LOUIS METELLUS
Kew Town
343-9786
BABYSITTER
REPORTS TO: DIRECT SALES MANAGER
LOCATION: PROVIDENCIALES, TURKS AND CAICOS ISLANDS
To support the direct sales team objectives and day to day activities with a highly professional service, encompassing floor management, team supervision, stock and display management, smooth running of all designated operations and to support a culture of continuous improvement.
• Assist in the preparation of regularly scheduled reports.
• Plan meetings and take detailed minutes.
• Supervises the function of the D2D and admin team contributes to maximizing the overall profit of the team and ensures customer best in class experience at all times.
• Meet financial KPIs.
• Monitor slow moving items and keep as low as possible to ensure inventory carried forward is kept at a minimum.
• Daily sales reconciliation.
• Coach, counsel and train employees.
• Identify market trends that appeal to customers.
• Ensure products are clean and ready to be displayed.
• Controls and analyzes stock availability and reconciliation.
• Utilize computers to record sales figures, data analysis and forward planning.
• Monitor local competitors.
• Organize and distribute staff schedules.
• Organize and distribute staff targets.
• Preside over staff meetings.
• Help, drive, motivate, and encourage sales staff to achieve sales target.
• Handle customer complaints, issues and questions
• You will be assigned to work at various locations (in store locations and pop up tents) on various islands (within the Turks and Caicos Islands) at the expense of the company.
• Any other duties as assigned by any person duly authorized and identified by the Company.
• This job description is not designed to cover or contain a comprehensive listing of activities, duties or responsibilities that are required of the employee for this job. Duties, responsibilities and activities may change at any time with or without notice.
QUALIFICATIONS AND EXPERIENCE REQUIRED FOR JOB:
• Minimum 5 CXC/GCE O ‘levels (including Mathematics and English Language)
• Excellent written, oral, and verbal communication skills
• Must have PC skills, including the ability to use Microsoft Office Suite
• Must have customer service skills
• Must have the ability to drive
• Must be able to work for at least 6-8 hours a day
• Spanish/Creole are an advantage
COMPENSATION
USD$24,000 per annum plus commissions.
DEADLINE:
Positions persons who are Turks and Caicos Island nationals or who have Belonger status. Interested applicants can forward their resumes to https://careers.digicelgroup.com/jobinvite/5128/ The closing date for applications is June 21, 2024.
$-8.00
Caring for my son by monitor him, bath & feed him, pick him up from school, wash, iron and clean the house
TINY’S RESTUARENT
346-3053
Long Bay Road
SERVER
$8.00
Taking customer order, serving food, drinks, receiving payment, clearing and cleaning tables after each use.
HANDU GUY CONSTRUCTION
331-6176
North Caicos
LABOURER
$8.00
To carry out and assist with continuous maintenance work, painting apartment interior & exterior and assist with construction work site
DENISE’S REPAIRABLE FURNITURE’S
345-5615
The Bight UPHOLSTERER
$10.00
Cover furniture frames with padding and fabric, using stitching, staples, tacks or glue. Make soft furnishings like cushions.
CHARLY RIGBY
Five Cays
343-1723
DOMESTIC WORKER
$8.00
Cleaning offices, cleaning toilet and caring for my home
DON FULFORD
241-2050
Juba Sound
HELPER
$8.00
Cleaning the property, pick up waste and dispose waste and assist with ongoing construction o the property
MERDEGRACE JOSEPH NICOLAS
346-1485

Wheeland LABOURER
$8.00
Cleaning outside the property, pick up yard waste and collect leaves, trash disposal, clean windows, and doorframes.
BLUE RISE CONSTRUCTION
Kew Town
345-1449
CLEANER
$8.00
Cleaning the offices, desk, windows, bathroom and maintain cleanness of the property
TINA’S VARIETY STORE
The Bight Gas Station (next to Mr. Gropper) 347-8780
STORE HELPER
$8.00
stocking the refrigerator & freezer, stocking shelves, restock products inside the store, assist customers with heavy lifting, export goods to customers vehicles, clean counters, dust shelves and product and maintain cleanness of the
ODINOR FRANCOIS
Blue hills
241-5739
MAINTENANCE WORKER
$9.00
Cleaning the property, assisting with ongoing construction on the property, maintain apartment complete maintenances.
ALL STARS BAR AND RESTUARANT
346-2332
Airport Road
SERVER
$8.00
Welcoming customers, taking customer, serving customers, giving change
CHARLES EQUIPMENT
RENTAL
243-1729
Five Cays
LABOUERER
$8.00
Cleaning the property, pick up waste, clean the bathrooms, and washing vehicles after uses

Minimum of 5 years’ experience in a kitchen. Help in preparing the menus and producing high quality dishes both in design and taste. Order supplies and ingredient to stock inventory properly. Effectively manage the kitchen staff, motivate them and assign duties. Manage and train kitchen staff, assist in establishing working schedules and assess staff’s performance. Must possess exceptional culinary skills and have a passion for food creation. Must be detailed orientation, well organized with advanced verbal and written communication skills, adapt quickly, multitask and work under pressure. Up to date knowledge about food preparation, food handling, health and safety standards and nutrition. Proficient in restaurant management software. Salary $30,000 per annum.
Minimum 5 years ‘experience in restaurant operation. Excellent communication and organizational skills; reading, writing, and oral proficiency in the English language. Excellent human relations skills; proven experience in dealing with employee and guest situations in a positive and effective manner. Must be an exceptional performer in their current job and demonstrate the potential for management. Train, evaluate, lead, motivate, coach, and discipline all employees in the service department to ensure that established cultural and standards are met. Salary $50,000 per annum.
Interested applicants are asked to submit their cover letter and resume to: INFO@EMBERS.TC
Only shortlisted candidates will be contacted. ALL APPLICANTS MUST HAVE A VALID POLICE RECORD WHEN APPLYING.

REPORTS TO: ASSISTANT SALES MANAGER
LOCATION: PROVIDENCIALES, TURKS AND CAICOS ISLANDS
JOB SUMMARY:
Selling Digicel products and services to new customers and up-selling and cross-selling to existing customers.
• Makes visits to assigned locations to promote and sell Digicel products and services.
• Contribute to and take part in sales promotions and events geared at increasing subscriber base
• Accurately record prospect info on signup sheet.
• Achieve sales objectives while providing the highest level of customer satisfaction.
• Provide relevant responses to customers concerns, products and service enquires based on actual facts related to the company’s products or services. Greet customers and ascertain what each customer wants or needs.
• Explains the benefits, value and usefulness of products to customers.
• Recommend device based on a customer’s needs and desires.
• Process all device sales, perform device checks and explain device warranty in accordance with Digicel policy.
• Responsible for all SIM sales and activations (prepaid)

QUALIFICATIONS:
• Master’s or bachelor’s degree in project management with three years plus in a similar position
• Experience working in the construction industry and the processes.
• Strong knowledge of construction accounting, including cost controls, job costing, and profit and loss accounting
• Exceptional knowledge of budgeting, and variance analysis
• Strong MS Office (especially Word & Excel) and accounting software skills (QuickBooks experience is beneficial.)
• Understanding of data analysis and reporting
• Excellent knowledge of standard operating procedures -
• Completion of multiple contracts meeting targeted milestones, budgets, and work quality.
• Responsible for code compliance, analyzed blueprints and specifications to forecast projects, and prepared estimates.
• Ensuring projects adhere to health and safety policies compliant with industry regulations relating to marine biology.
• Create project schedules, daily reports, track, and submit weekly payroll cost and sub-contractors estimates, and prepare vendor contracts.
• Project material projection and procurement. The salary is based on experience.

• Sell and upgrade Cable services and Broad band services in accordance with company goals and customer needs.
• Troubleshoot customers’ service problems, schedule field service calls when necessary.
• Handle all account adjustments and corrections.
• Troubleshoot and resolve customer handset issues and requests.
• Report all customer complaints in timely manner.
• Adhere to cash handling procedures
• Adhere to uniform strict policies
• Configure APN, set up email addresses and applicable apps, and take any other action necessary steps to ensure that the customer is able to use voice, sms and data when he/she leaves the store.
• You can be assigned to work at any Digicel retail store in expense of the company.
QUALIFICATIONS AND EXPERIENCE REQUIRED FOR JOB:
• Basic computer skills
• Knowledge of the Internet
• Previous sales experience, with demonstrated success is an asset.
• Previous experience in a customer service environment is an asset.
USD$24,000 per annum plus commissions.
Positions persons who are Turks and Caicos Island nationals or who have Belonger status. Interested applicants can forward their resumes to https://careers.digicelgroup.com/job-invite/5128/ The closing date for applications is June 21, 2024.

Sean “Diddy” Combs has sold a majority stake in Revolt, the media company and television network he founded in 2013, according to the company.
Revolt, a Black-owned multiplatform media company, has announced its largest shareholder group is now its own employees. In a press release, a spokesperson for Revolt said that the new ownership model ensures that employees who are driving the company’s growth can also benefit from its success, aligning with an emerging industry trend of equity participation.
“Today, we are most proud of the transformation that our teams will experience as they shift from being employees to owners of the business they are helping to build,” CEO Detavio Samuels said in a statement on Tuesday. “Black culture is global culture, and
Revolt’s superpower is being the home for creators that move culture globally, allowing us to build the most powerful storytelling engine for Black voices.”
A spokesperson for Revolt said that shares held by Combs have been “fully redeemed and retired.”
Representatives for Combs did not immediately respond to CNN’s request for comment.
Combs stepped aside as chairman of Revolt in November, after he was named is several civil lawsuits in which he has been accused of sexual assault and other illegal activity. Combs has vehemently denied claims from many of the civil suits but has not responded to all of the allegations.
Last month, CNN published a 2016 surveillance video that showed Combs physically assaulting Cassie Ventura, a
former girlfriend who filed a nowsettled civil suit against Combs in November 2023.
Combs apologised for his actions in the video nearly two days after CNN’s report was first published.
Meanwhile, federal investigators are preparing to bring accusers of the music mogul before a federal grand jury, according to two sources familiar with the probe — signaling the US Justice Department is moving toward potentially seeking an indictment of Combs.
Federal investigators are also looking into allegations of money laundering and illegal drugs, CNN previously reported.
Revolt Media was founded by Combs in 2013 with the intention of highlighting Black culture and hip-hop. (CNN)

“Girls Just Want to Have Fun” and “Time After Time” singer Cyndi Lauper has announced her farewell tour.
In what will be her first major tour in more than a decade – and her final – the Brooklyn-born singer-songwriter will headline concerts at 23 cities across North America from October 18 to December 5, according to events promoter Live Nation.
Also known for songs such as “True Colors” and “All Through the Night,” the twotime Grammy winner will start her tour at the Bell Centre in Montreal in Canada’s Quebec province. She’ll later make her way to Madison Square Garden in her hometown New York City on October 30, and will eventually reach her last stop at
the United Center in Chicago, Illinois.
Throughout her tour, Lauper will be joined by special guests, who will be announced at a later date, Live Nation said in a press release Monday.
Tickets will be available from Tuesday through an artist presale. More presales will also take place leading up to the general sale on Friday on Live Nation’s website.
A documentary exploring Lauper’s life and career will also air on Paramount+ on Tuesday in the US and Canada. Directed by Alison Ellwood, “Let the Canary Sing” chronicles Lauper’s rise to stardom, her ever-evolving and influential punk-style, and her advocacy work, according to the release.
Stars including Keira Knightley and Ruth Wilson have signed an open letter calling on firms to support a crackdown on bullying and sexual harassment.
The letter urges creative organisations to help fund a new watchdog, the Creative Industry Independent Standards Authority (Ciisa), which will investigate complaints in the music, film, theatre and TV industries.
“Bullying and harassment claims in the industry continue abound,” the letter said.
It added that the new body is “very necessary” to help to drive change.
Actresses Cara Delevingne, Carey Mulligan, Rebecca Ferguson, Naomie Harris and Emerald Fennell have also put their name to the letter.
Male actors and performers

Keira Knightley is among the stars who have signed an open letter to creative organisations
including Guy Remmers, Jonny Sweet, Joshua McGuire and Rob Cawsey have also signed.
The BBC, Sky, ITV, Channel 4 and Viacom already made an initial
payment to support Ciisa.
“We are calling on you to make your final commitment to the creation of Ciisa... to keep our creative industries safe,” the stars
wrote.
“So many of us in this industry would have loved to have an objective outside body that we could go to for advice, for mediation and in the very extreme circumstances, that we might need some outside body to hold people accountable for the bad behaviour or bad practices that sometimes happen on our sets, on our stages, behind the scenes.”
The letter said creative industry professionals from film, TV, music and theatre had recognised the need for such a body.
It added it hoped that the new watchdog would become “the blueprint across the globe for keeping our creative industries safe”.
“We want to thank those organisations that have already taken the bold step to make the
final financial commitment, and we urge those that have yet to do so, to join us so that we can turn Ciisa into a reality.”
Last week, the trade union Bectu published research suggesting that 92% of creative workers have witnessed or experienced bullying or harassment at work.
It found that one in five people working in the UK’s creative industries have experienced a serious sexual assault while at work.
Bectu has also called on broadcasters, studios and streamers to financially back Ciisa.
“It’s no secret that sexual harassment remains a scourge on the creative industries,” said head of Bectu Philippa Childs.
“The mental toll and widereaching impacts of workplace sexual harassment can be absolutely devastating,” she said.

EGOT-winner Barbra Streisand was moved to make new music for an upcoming television series that both examines history and sheds light on an issue that persists in the present day.
The recent SAG life achievement award recipient has recorded a new song, titled “Love Will Survive,” to be featured in next month’s Peacock series “The Tattooist of Auschwitz,” the streamer announced Wednesday.
“Because of the rise in antisemitism around the world today, I wanted to sing ‘Love Will Survive’ in the context of this series, as a way of remembering the six-million souls who were lost less than 80 years ago,” Streisand said in a statement. “And also to say that even in the darkest of times, the power of love can triumph and endure.”
The song was composed by Oscar-winner Hans Zimmer in collaboration with Kara Talve and Walter Afanasieff. With lyrics by Charlie Midnight, it is Streisand’s first-ever recording for a TV series. She is accompanied on the track by the London Symphony Orchestra, conducted by William Ross.
“The Tattooist of Auschwitz,” based on the novel by Heather Morris, stars Harvey Keitel, Melanie Lynskey, Jonah HauerKing, Anna Próchniak and Jonas Nay.

“Boy Meets World” actress Trina McGee’s family is growing.
McGee announced on her Instagram page on Monday that “at the tender age of 54, I have found myself pregnant.”
“Please bless us with your prayers for a safe delivery,” she added, writing in the caption that she’ll be also taking a break from social media for some time.
This will be McGee’s fourth child. She has been married to actor Marcello Thedford for 16 years, according to People, but has three children from previous relationships.
McGee appeared on “Boy Meets World” from 1997 to 2000 playing

McGee appeared on
Angela Moore, the girlfriend of Shawn Hunter (Rider Strong).
According to data reported by the CDC in 2023, women are having babies at older ages while
birth rates have declined in most states across the US in recent years.
The decline in birth rates can be explained, in part, by the increasing age of first-time mothers.


Alec and Hilaria Baldwin announce TLC reality series about their family
Alec and Hilaria Baldwin are bringing their large family and their expected big adventures to TLC.
The couple and the network simultaneously announced Tuesday that they will be the focus of a reality series about their family, set to debut on TLC in 2025.
In the video announcement shared on social media, the pair joke about an “announcement” with Alec Baldwin saying, “Good God no!”
“No definitely not. We’re done having kids,” his wife responds.
They then cut to all the chaos that would be expected from a family that includes seven children under the age of 10.
“We’re inviting you into our home to experience the ups and downs; the good, the bad, the wild and the crazy,” Alec Baldwin says in the video. “Home is the place we love to be most.”
“Alec and Hilaria Baldwin have been making headlines since they were married nearly 12 years ago,”
a representative for TLC said in a statement. “For the first time, they’re opening up their family lives and bringing everyone in to join in the non-stop love, laughter and drama.”
TLC, like CNN, is part of Warner Bros. Discovery.
In addition to his seven children with Hilaria, Alec Baldwin also has an adult daughter, Ireland, from his previous marriage to Kim Basinger. Baldwin became a firsttime grandfather when Ireland welcomed her own daughter last year.
Baldwin has more recently made headlines for his an ongoing legal issues.
He has pleaded not guilty to an involuntary manslaughter indictment against him in the “Rust” fatal shooting case, connected to the 2021 death of the film’s cinematographer, Halyna Hutchins. The trial is scheduled to start in July in New Mexico.
“The Baldwins” is the working title for the new show. (CNN)





( SECTION 4(3) OF THE TURKS AND CAICOS ISLANDER STATUS ORDINANCE)
Take notice that I, Dileeni Daniel-Selvaratnam, Governor of the Turks and Caicos Islands in exercise of the powers conferred in me by Section 6(4) of the Turks and Caicos Islander Status Ordinance intend to grant a Certificate of Turks and Caicos Islander Status to Nicolas Marc by virtue of marriage to a Turks and Caicos Islander.



( SECTION 4(3) OF THE TURKS AND CAICOS ISLANDER STATUS ORDINANCE)
Take notice that I, Dileeni Daniel-Selvaratnam, Governor of the Turks and Caicos Islands in exercise of the powers conferred in me by Section 6(4) of the Turks and Caicos Islander Status Ordinance intend to grant a Certificate of Turks and Caicos Islander Status to Alenus Augustin by virtue of marriage to a Turks and Caicos Islander.


The Turks and Caicos Islands oldest and leading publishing house is in need of additional staff to fill the following posts:
Candidates must have at least five (5) years’ experience working full-time for daily newspapers and/or news/features magazines, reporting on hard news, features and parliamentary/court proceedings. Salary paid weekly will commensurate with experience.
This position requires someone with at least five (5) years’ experience working with Macintosh or PC computers. Must be skilled in the make-up of advertising and pagination. Proficiency using InDesign, Illustrator and Photoshop software for print is essential. Some technical, networking and web design knowledge an asset. Salary paid weekly will commensurate with experience.
College or high school graduate with at least five (5) years’ experience in community reporting. Ability to drive and use a camera a desirable asset. Salary paid weekly will commensurate with experience.
Candidates must have had actual hands-on experience selling advertising space for newspapers and magazines. Ability to assist clients with the writing of copy for ads and gathering of collateral an asset. Salary is commission based.
REQUIREMENTS:
• Recording day to day financial transactions and completing the posting process
• Verifying that transactions are recorded in the correct day book, suppliers ledger, customer ledger and general ledger
• Bringing the books to the trial balance stage
• Record day to day financial transactions and complete the posting process
• Verify that transactions are recorded in the correct day book, suppliers ledger, customer ledger and general ledger
• Bring the books to the trial balance stage
• Perform partial checks of the posting process
• Complete tax forms
• Enter data, maintain records and create reports and financial statements
• Process accounts receivable/payable and handle payroll in a timely manner
QUALIFICATIONS:
• Proven bookkeeping experience
• Solid understanding of
receivable principles
• Hands-on experience with
• Proficiency in English and in MS Office
• Customer service orientation and negotiation skills
• High degree of accuracy and attention
DUTIES: Keeping the house clean, Dusting, Sweeping, Ironing, taking out trash, ensuring the yard cleaning is organized and the upkeep of the house with all cleaning and food supplies is stocked. REQUIREMENTS:
To be Capable of working independently with minimal or no supervision. SALARY: $8.50 hourly


Location: Salt Mills, Grace Bay, Providenciales, Turks and Caicos Islands
POSITION OVERVIEW:
This is a specialized nursing role designed to provide expert clinical care and psychotherapeutic intervention for patients dealing with traumarelated mental health issues. The CNS will integrate advanced nursing practices with Somatic psychotherapeutic techniques, specifically utilizing Compassionate Inquiry and Internal Family Systems (IFS) methodologies, supporting patient recovery and promote mental health wellbeing.
ESSENTIAL CRITERIA:
• Registered General Nurse with 3-5 years minimum of clinical experience.
• Must have experience in Compassionate Inquiry and Internal Family System methodologies.
• Must demonstrate trauma-informed care and psychotherapeutic interventions expertise.
As a Digicel Retail Sales Executive you will wear many hats. The listed responsibilities below will be assigned to you by your supervisor on a rotating basis, as needed. Whatever role you are assigned to play, your responsibilities fall within these four main areas:
RESPONSIBILITIES:
• Greeting
• Floor Walking
• Cashing
• Sales ACADEMIC QUALIFICATIONS AND
EXPERIENCE REQUIRED:
• Minimum 5 CXC/GCE O'levels (including English Language and Mathematics or numerical equivalent)
• Minimum requirement of intermediate computer skills
• Proficiency in using Microsoft Word
• Previous sales experience, with demonstrated success in a customer service environment is an asset
• A second language is an asset (Spanish, Creole, or French)
• Full understanding and proficiency of smartphones, apps, and social media
join our team and help drive our operations to success. KEY RESPONSIBILITIES:
Oversee day-to-day administrative operations, Coordinate office activities and operations to secure efficiency and compliance with company policies. Assist in the preparation of budgets, reports, and financial data. Handle confidential
information with integrity and discretion. QUALIFICATIONS: Bachelor’s degree in Bus. Administration or related field. Proven experience in administrative roles. Strong organizational and time-management skills. Excellent communication and interpersonal abilities. Proficiency in MS Office and office management software, WorkPal Software, Ajax software, Shift planning software. Remuneration based on experiencecommencing at $2600.00 monthly.

JOB DESCRIPTION
• Perform maintenance and repair on customer vehicles.
• Identify problems with vehicles using the diagnostic equipment.
• Explain automotive repairs and issues and provide great customer service.
• Plan repair procedures using charts manuals and experience.
• Test the functionality of parts and systems
DUTIES & RESPONSIBILITIES:
• Preparing and completing warehouse orders for delivery or pickup according to schedule
• Receiving and processing warehouse stock products
• Performing warehouse inventory controls and keeping quality standards high for audits
• Completes shipments by processing and loading orders.
• Prepares orders by processing requests and supply orders; pulling materials; packing boxes; and placing orders in the delivery area.
• Enforces inventory controls by collecting stock location orders and printing requests.
• Provides quality service by following organization standards.
• Preserve a safe and clean work environment by keeping shelves, pallet areas, and workstations neat.
• Promotes clean shipping supply area by complying with procedures, rules, and regulations.
• Completes reports by entering required information.
• Contributes to team effort by accomplishing related results as needed.
DUTIES INCLUDE BUT ARE NOT LIMITED TO:
• Cleaning the outside of the villa and property as required
• Collect and dispose of garbage and debris including removing leaves
• Assist with carrying watersports equipment to and from the beach
• Set up/disassemble equipment as necessary
• Repair and replace brake pads, wheel bearings, sensors, and other parts.
• Perform routine maintenance and general mechanic work on vehicles.
• Prepared to get the additional certification as needed.
• Willingness to learn with hands-on training.
• Help keep repair shop clean and organized.
• Perform basic auto care and maintenance tasks such as oil changes, fluid level checks, and tire rotation.
• Keep a professional appearance.
• Assist with trim carpentry and perform basic maintenance
• Must be able to fill in gaps on walls, floor repairs and upkeep
• Must be willing to take instructions and work along with the team
• Must have a clean police record
• Compensation for either position is starting at $8.00 hourly


JOB
Responsible for the installation, repair, and maintenance of various gaming and electronic equipment, ensuring optimal operations.
• Rebuild, repair, modify and install gaming devices of all types and associated equipment
• Install, remove, set options, repair and troubleshoot online management systems, cash dispensing safes, progressive systems and signs
• Run and terminate CAT 5 and 6, fiber, coaxes and installs patch panels
• Maintains safe working equipment and maintain tidy areas.
• Ensure compliance with all applicable gaming laws and company internal controls, policies and procedure
• Responsible for the execution and recording of preventive maintenance programs as instructed by the slot tech manager
• Complete all paperwork accurately and submit any performed task at end of day.
• Woodworking, laminating, painting, and cleaning, polishing, loading and unloading equipment.
• Provide outstanding guest service in a timely manner to both guests and fellow team members that meets the company’s guest service culture standards
• Maintains all information confidentially.
• Applicants must have some knowledge in the gaming field, machine trouble shooting testing and repair.
• Must show excellent customer service skills and show the ability to communicate efficiently and effectively with customers, subordinates, and management and gaming regulatory organizations.
• Electronics qualifications are a must.
• 3 years minimum experience in a similar role.
• Must be able to lift up to 50lbs and speak, read and write fluent
• Must be computer literate in Excel, word and


• Knowledge of the installation and operation of irrigation systems and components.
• Knowledge of work methods, tools, equipment and materials used to maintain and repair irrigation systems
• Knowledge of electronically controlled irrigation systems and programming functions
• Knowledge of drip irrigation systems
• Skill in reading construction drawings, blueprints, plans and specifications
• Skill in maintaining records of the installation and maintenance of irrigation systems
• Ability to diagnose and troubleshoot irrigation problems
• Ability to work both independently and with others
• Ability to follow verbal and written instructions
• Ability to fine tune irrigation systems to optimum operating potential
• Ability to troubleshoot pumping systems and remove and install pumps.
• Ability to install and replace faulty valves and solenoids
• Repairs of piping of all types
• Direct, train, and evaluate subordinate personnel.
• Coordinate, assign, and review the work of assigned maintenance personnel
• Review work orders and schedule personnel and equipment in accordance with job requirements
• Plan and recommend materials needed for work projects; order approved supplies and materials
• Prepare and maintain maintenance logs of work performed
• Order supplies; keep time sheets; assist with budgeting; complete written records of work performed, material/labor estimates and training
• Respond to inquiries from company client’s
• Safely operate and maintain a variety of related tools, power, and agricultural related equipment
• Build and maintain positive working relationships with co-workers, other contractors employees and the public using principles of good customer service
Salary 8/hr


( SECTION 4(3) OF THE TURKS AND CAICOS ISLANDER STATUS ORDINANCE)

• Suitable Candidate should have a minimum 2 years of solar PV installation Experience.
• Candidate should have handson experience of installing grid tied, grid. interactive and off-grid renewable energy systems
• Knowledgeable of the solar industry.
• Must be able to read engineering drawings.
DUTIES/RESPONSIBILITIES
• Install renewable energy systems.
• Maintain renewable energy systems.
• Review and research alternative new forms of renewable energy, suitable for this market.
• Liaising with clients and consultants
Salary: $12 an hour.

Grant Thornton Turks & Caicos Ltd (“GT”) is a member firm of the Grant Thornton International network and has an opportunity available in our firm for an:

• Corporate services – assist in the provision of corporate services to clients, including new company applications, annual filings and liaison with the Company Registry and Financial Services Commission.
• Support in Office Administration and Finance functions and other ad hoc tasks.
• Reception – responsible for greeting guests, taking calls, and dealing with couriers.
& QUALIFICATIONS
• Strong client service focus in dealing with both external and internal clients, displaying professionalism, integrity and tact.
• Proficiency to work with MS Office (Word and Excel) with strong judgement and problem solving, organizational and communication skills.
Salary Range: $20,000 to $30,000, based on experience
Take notice that I, Dileeni Daniel-Selvaratnam, Governor of the Turks and Caicos Islands in exercise of the powers conferred in me by Section 6(4) of the Turks and Caicos Islander Status Ordinance intend to grant a Certificate of Turks and Caicos Islander Status to Emile Andrae Simms by virtue of marriage to a Turks and Caicos Islander.
• Hold a minimum of 4 years’ experience in the field of finish carpentry – including, but not necessarily
• limited to, internal doors & frames, baseboards, lumber roof finishes and millwork in general.
• Some experience in rough carpentry (formwork etc.) would be an asset – but not essential.
• Have a concise understanding of all finish carpentry materials and be able to fully interpret, read and
• understand architectural and shop drawings and have a very high level of finishes experience.
• Employee must be fluent in

written and oral English. (French and Spanish would be an asset)
• Employees will also need to be computer proficient as many drawings and schedules being used on site will be computer/ tablet based not in the form of hard paper drawings.
• Must be able to work under own direction and able to manage subordinates.
• Must be willing to work outside of the normal working hours of operation (weekends and public holidays)
• Salary $15 per hour (subject to overtime and public holiday pay where applicable)

Wymara Resort + Villas is a contemporary luxury full-service boutique resort on Grace Bay Beach. We are looking for driven and energetic professionals with minimum Four to Five-Stars Forbes experience and who are committed to achieving excellence by ensuring five-star standards and services are continuously delivered.
Responsible for providing the Chief Executive Officer, Ownership and Executive Committee Member with meticulous and methodical administrative support including keen organizing, planning, travel management, expertise in coordinating documents, reports, and records, handling correspondence and general accounting principles. Must be personal with exceptional oral and written communication skills paired with relationship-building qualities. Prepare complex numerical/financial reports, conduct research using various media sources to obtain relevant data. Master’s in Business Administration in Human Resource Management & Travel and Tourism. Proven previous experience as Executive Assistant for 5+ years. Compensation: $25K- $30K per annum.
Provide quality dishes which have been prepared, cooked, and presented according to company standards and within the timescales required for Indigo and Blue Water Bistro restaurants. Liaise with kitchen staff, food service or bar staff and restaurant management regarding customers’ orders and general service of kitchen operations. Maintain a safe and hygienic working environment, including proper storage of food and equipment. Compensation starts at $8.00 per hour.
The applicant is required to have at minimum a 200-hour Yoga Alliance Certification/ Group Fitness/ Barre Certification. Minimum 5+ years teaching experience and actively teaching. Current Liability Insurance and CPR Certification. Be willing and available to teach on average 4+ classes per week. Genuine ability to connect with complete strangers on a personal level and demonstrate the ability to teach a safe, fun, and creative class with a genuine interest in student success.
• The successful applicant will also need to have an outgoing personality with a strong desire to provide great client service. Have a strong desire to grow and the ability to take on and integrate feedback. Create a personal connection with each student and follow up with students after class. Set up the classroom appropriately: props, mat spacing, music, lighting and be prepared to keep the studio space clean and organized. They must provide top-notch class instruction that is consistent with the class format and teaching methodology.
• Instructor will need to be flexible with work time and open to teach mornings, evenings, weekends, and public holidays as the schedule dictates. Applicant must speak English and must be a team player. Instructors who meet our initial standards will be contacted to schedule a preliminary audition. Further training will also occur before teaching commences.
Salary: Commission based.

Reporting to the Director of Engineering, the Assistant Director of Engineering will assist with managing all aspects of the Engineering Department including ensuring compliance with all local and state building codes and quality standards. Responsibilities span a broad spectrum, covering all the areas of project management such as Project Planning, Cost Management, Inventory Management, Time Management, Quality Management, FF&E Management, and overviews Health & Safety. Pre-opening experience is essential with proven ability to successfully lead comprehensive renovative and maintenance projects to completion and on schedule. Must have at least 10-15 years’ experience in Engineering, Facilities, Property Management, with working knowledge of hotel and villa operations in a similar position and knowledgeable in all disciplines of maintenance/engineering. Advanced degree with distinction in Mechanical/Electrical Engineering. Advanced Degree with distinction in Business, Commerce and Management Studies. Compensation: $40K - $50K per annum.
Reporting to the Butler Experience Manager, the ideal candidate will manage all aspects of the guest’s experience to ensure flawless, uncompromised, and personalized luxury service. Maintain outstanding relationships with and provide superior service to guests and owners. Advanced knowledge in Forbes Five-Star Service Standards. Must be personal with exceptional oral and written communication skills. Protect confidential data and restrict communications of same only to authorized persons. Perform other duties as directed by the General Manager or any other authorized Executive. Monitors training employee progresses to ensure Wymara standards are implemented and followed. Compensation: $25k - $30k per annum.
Reporting to the Front Office Manager, the applicant must have excellent communication, organizational, problem resolution and conflict management skills, at least 2 years’ experience in four- or five-star hotel front desk operation and maintain a presentable image consistent with Forbes Standards. Technical skills include Microsoft Office suite and Opera PMS. Applicant must have exceptional customer service and experience with Forbes and LQA Standards. English language required with additional languages an asset. The position requires flexibility in scheduling and the ability to handle confrontation and complaints with patience and diplomacy. Compensation starts at $9.00 per hour.

InterHealth Canada Construction & Services is currently recruiting for Key positions within TCI Hospitals. Successful candidates will be offered excellent packages depending on qualifications and experience.
– PROVIDENCIALES
Looking for experienced professional housekeepers to perform all cleaning duties to support the team in maintaining a clean environment, whilst adhering to Hospital Infection Control policies and procedures. Previous experience is essential. Shifts include 7 a.m. to 4 p.m., 8.00a.m. to 5.00 p.m., and 11 a.m. to 8 p.m. Rate of Pay $9.00 per hour.
– PROVIDENCIALES
Positions are available for the kitchen assistant role. Duties include food service to the public and patients, cash handling, basic food production, cleaning duties, due diligence recording, and customer service. Previous experience is essential. Shifts 6:30 a.m. to 3:30 p.m., and 11:30 a.m. to 8:30 p.m. Rate of pay is $9.61 per hour.
– PROVIDENCIALES & GRAND TURK
Challenging, fast-paced patient-facing post with duties that include transportation of patients, and movement of specimens, equipment, and supplies. Also includes Hospital standard cleaning duties and deep cleaning processes, waste collection, and support for Security Services. Shifts include 6.30 a.m. to 3.30 p.m., 8.00 a.m. to 5 p.m., 2.00 p.m. to 11.00 p.m., and 10.00 a.m. to 7.00 p.m. Rate of pay $9.61 per hour.
– PROVIDENCIALES & GRAND TURK
Carries out general Laundering duties under the direction of the supervisor. Complies with health and safety standards at TCI Hospitals. Shifts are 6:45 a.m. to 3:45 p.m., 9:00 a.m to 6:00 p.m and 11:00 a.m to 8:00 p.m. Rate of pay $9.00per hour.
REQUIRED - (GRAND TURK & PROVIDENCIALES)
• Applicants must be able to work 40 hours per week (5 shifts allocated over 7 days and including weekend working and bank holidays). Candidate must be qualified to a Bachelor’s Degree or equivalent, and hold qualifications in Mechanical and/or Electrical Engineering.
• Duties include but are not exclusive to: Prevented Planned Maintenance on all HVAC, VSD, pumps and motors, valves and strainers, reactive works on all plants, fault finding, and correction. Fabric maintenance of the building, and handyman tasks if and when required. Trade tests and competency programs will be included at the interview stage.
• *Salary: $40k
Qualified Belongers will be given first consideration.
- (CHESHIRE HALL MEDICAL CENTRE, PROVIDENCIALES & COCKBURN TOWN MEDICAL CENTRE, GRAND TURK)
• The ideal candidate should possess a Bachelor’s degree or its equivalent in Mechanical and Electrical Engineering, along with qualifications in Health & Safety (NEBOSH/IOSH), Medical Gas Safety and must be proficient in IT software’s. Additionally, a minimum of 5 years of experience in a similar role is required.
• Applicants must be able to work 40 hours per week (5 shifts allocated over 7 days and include weekend working and bank holidays).
• Departmental head responsible for effective daily running of Engineering Department. Responsible for a team of 3-5 engineers, grounds maintenance persons and handymen. Ensuring timely completion of work orders, PPM’s, reactive tasks and daily operational activity. Supervises and supports team working on a wide range of engineering plant and equipment (both electrical and mechanical systems).
• *Salary: $65k plus (dependent on experience)
– PROVIDENCIALES
• Responsible for operations of daily kitchen, food production, HACCP, due diligence, Catering Budget patient and retail menu compilation and costing and stock management. Also responsible for training and development and management of catering team.
• *Salary: Starting $50k plus
• Excellent customer service skills, communications skills, good standards of spoken and written English are required for all posts. Appointments will be granted upon a successful interview, positive reference check, clear Police check, satisfactory health assessment, and proof of Covid vaccination.

REPORTS TO: SALES MANAGER
LOCATION: PROVIDENCIALES,
To provide comprehensive administrative support to the FTTH Service Delivery and FOTs Team by effectively managing the daily administrative functions to support the sales and service delivery process. Full utilization of ALL resources within your assigned purview to meet and exceed business objectives.
• Support the FOTs team with troubleshooting requests.
• Conduct daily reports and reconciliation for the sales support function and accurately collate details for submission to the FTTH Service Delivery Manager
• Responsible for managing all travel arrangements for FTTH Technical Team
• Monthly submission and reconciliation of invoices for third party contractors affiliated with our FTTH operations. This may include but is not exclusive to drivers, technicians or their parent company and promotional agents. Must consistently meet required deadline for submission.
• Data analysis derived by cross referencing relevant application/systems used to mine company data and provide business intelligence, to support critical decision making.
• Follow through on order fulfillment process to ensure goods and services are received by H&E business unit.
• Enforce existing company processes to support best business practices geared at enhancing efficiency across the Service Delivery and Commercial Teams. Make recommendations for process implementation and improvement where necessary.
• Conduct inter-department (independent) customer satisfaction audits on a monthly basis and track responses for review.
• Overall responsibility for maintenance and dissemination of all service delivery installation and service call reports.
• Conduct weekly, monthly and quarterly audits of all sales tools and peripherals. Ensure that all staff members are in adherence to company safety policies and guidelines that govern same. Maintain database of all assigned equipment (Sales & Service Delivery)
• Maintain electronic and hardcopy files for all
agent/customer transactions. All documentation must be stored in chronological order and be made available to both external and internal auditing teams when required.
• Report immediately to the Management Team any malpractices or events that have or may lead to the company, its staff or its customers being in disrepute.
• Garner extensive knowledge of all support software used to facilitate backend processing and data capture. Will be responsible for training Admin, Sales Team and other key personnel on the use of mentioned software.
• Follow-up on incoming issues and concerns addressed to the FTTH LEAD, including those of a sensitive or confidential nature and may be required to determine appropriate course of action, referral, or response.
• Any other duties as assigned by any person duly authorized and identified by the Company.
• This job description is not designed to cover or contain a comprehensive listing of activities, duties or responsibilities that are required of the employee for this job. Duties, responsibilities and activities may change at any time with or without
ACADEMIC QUALIFICATIONS AND EXPERIENCE REQUIRED FOR JOB:
• A minimum of diploma in secretarial or administrative studies or related field
• At least five (5) years’ experience in an administrative/support role.
• Knowledge of the payroll function and very detailed reporting
• Experience in supporting a mid-sized – large business unit
COMPENSATION
USD$24,000 per annum
Deadline:
Positions open to all qualified Turks and Caicos National/Belonger. Interested applicants can forward their resumes to https://careers. digicelgroup.com/job-invite/5471/. The closing date for applications is June 21, 2024.



Understands concepts such as being pro-active, friendly but not too familiar, courtesy, privacy and confidentiality, invisible yet available. To assist in overseeing other villa staff as required, so must have supervisory experience at luxury hotel or villa properties.
KEY FUNCTIONS INCLUDE:
• Assist with luggage upon arrival/departure of guests
• Operation of electronic systems in villas including music, television, security, lighting, pool/spa etc.
• Oversee and/or participate in formal table setting and service, knowledge of wines and spirits and bartending, serving meals and beverages
• Keep household inventory and supplies
• Light housekeeping duties when necessary
• Pre-empt maintenance issues and report issues to property manager
• Coordination of contractors and repairs
• Self-motivated and takes initiative
• Oversee groundskeepers in management of pool, outside areas and gardens
• Excellent communication skills and attention to detail, ability to communicate efficiently with chef and concierge team as well as directly with guests
• Must speak English fluently. Additional languages a plus.
• 5 – 10 years’ experience required
Starting salary $24,000 per year based on experience and references. This is a new position.
Understands concepts such as being anticipatory, friendly but not familiar, privacy and confidentiality. To assist in overseeing housekeepers and laundry staff so must have supervisory experience at luxury hotel or villa properties.
KEY FUNCTIONS INCLUDE:
• Housekeeping and laundry staff across multiple villas
• Perform and schedule daily cleaning and laundry responsibilities to the highest standards with impeccable attention to detail
• Organize and perform deep cleaning as needed
• Knowledge of proper care and maintenance of furniture, countertops and upholstery
• Organize and maintain on-property storage and laundry facilities
• Ability to communicate clearly with guests in a professional and friendly manner
• Self-motivated and takes initiative
• Must speak English fluently. Additional languages a plus.
• 5 – 10 years’ experience required
Starting salary $18,000 per year based on experience and references, accommodations/utilities provided and must live on site. This is a new position.

Experienced full-time and live-in Nanny/Housekeeper is needed for a private home in Providenciales. Applicants must speak English and Spanish, be fit and able and be prepared to work evenings and weekends.

Are you passionate about data analysis and eager to kick-start your career in a dynamic and innovative environment? We are currently seeking a dedicated Assistant Analyst to join our growing team.
KEY RESPONSIBILITIES:
Assist in collecting, analyzing, and interpreting data to provide valuable insights. Support the preparation of reports and presentations for internal and external stakeholders. Collaborate with team members to identify trends and patterns in data. Help maintain databases and ensure data accuracy. Contribute to the continuous improvement of data analysis processes.
QUALIFICATIONS:
Bachelor’s degree in a related field (e.g., Statistics, Economics, Business Administration). Strong analytical skills and attention to detail. Proficiency in data analysis tools such as Excel, SQL, or others. Excellent communication and teamwork skills. Ability to work in a fast-paced environment and manage multiple tasks effectively. WorkPal Software, Ajax software, Shift planning software.
“absolutely gutted” that he will have to miss Euro 2024 through injury.
The 31-year-old and Manchester City forward Jack Grealish, both regulars in Gareth Southgate’s England squad, have not made the final 26-man list.
The central defender Maguire has not recovered sufficiently from a calf injury he sustained in April which kept him out of United’s FA Cup final victory over Manchester City last month.
In a post on social media,, external Maguire, who has represented the Three Lions on 63 occasions, confirmed he would not be playing in Germany.
He said: “I’m devastated
not to have been selected to play for England at the Euros this summer. Despite my best efforts, I’ve not been able to overcome an injury to my calf. Maybe I pushed myself too hard, to try and make it. Simply, I am absolutely gutted.”
Burnley goalkeeper
James Trafford, Everton defender Jarrad Branthwaite, Liverpool’s Jarell Quansah and Curtis Jones and Tottenham midfielder James Maddison have all also missed out.
“For me, representing England is the highest honour,” Maguire, who was in Southgate’s initial 33-man selection, added. “It means everything to me. If I can’t

help the team as a player, I will support them as a fan – along with the rest of the country. Go and win it boys.
“Next, I will return to the supervision of the Manchester United medical team in order to prepare for next season.”
Earlier on Thursday it was
confirmed Tottenham forward Maddison, 27, and Liverpool midfielder Jones, 23, had both left the training camp.
In a post on social media, Maddison wrote of his disappointment, saying “devastated doesn’t quite cut it”. He added: “I still thought there would be a space for me
in a 26-man squad as I feel I bring something different and had been a mainstay in this whole qualifying campaign for Euro 2024 in Germany.
“But the manager has made the decision and I have to respect that. I’ll be back, I have no doubt.”
•
•
•
Providenciales Tel: 649-241-4107
DOMESTIC WORKER $8.00 p/h
Perform Cleaning, loundering and other housework
MAGGY MILLIEN Blue Hills Tel: 342-9776 CLEANER $8.00 p/h Dusting,
•
•
•
•
•
• Ability to operate Point-of-Sale and Kroll programs
• Possesses excellent communications and interpersonal skills
• Competent and reliable professional, committed and experienced
SALARY: 50K PER ANNUM
Even as the United States grapples with an outbreak of H5N1 flu in dairy cattle, the World Health Organization has announced the first known human infection with a different strain, H5N2, in a person in Mexico who died of complications of their infection.
Both of these strains of the influenza A virus have primarily affected farmed and wild birds, infecting flocks around the world. About 900 human cases of H5N1 have been reported since 1996, and about half of people known to be infected have died. On Wednesday, WHO said it had confirmed the first case of human infection of H5N2 in a 59-year-old resident of Mexico.
The source of the person’s infection is unknown, although WHO noted that H5N2 viruses had been reported in poultry in Mexico.
Because any new influenza A infection in people has the potential for high public health impact, it must be reported to WHO. The
organization said that based on current knowledge, the risk to the general public from H5N2 is low, since other H5 subtypes are known to infect humans but none has been shown to cause sustained humanto-human spread.
The person, who had multiple underlying medical conditions, had been bedridden for three weeks for other reasons before they developed new symptoms. In mid-April, they developed fever, shortness of breath, diarrhea, nausea and weakness. On April 24, they sought medical attention and were hospitalized at the National Institute of Respiratory Diseases in Mexico City. The person died of complications that day.
On May 8, a sample sent for specialized testing indicated that it was positive for H5N2, and the result was subsequently confirmed by a different lab.
Of 17 people at the hospital who’d been in contact with the

patient, no further cases were identified. Twelve additional contacts were identified near the person’s residence, and seven of those had symptoms, but testing of samples from these cases didn’t identify Covid-19 or any type of flu. Scientists are now testing blood samples to see whether they can find antibodies that would point to past infections.
In March, an H5N2 outbreak
was reported in a backyard poultry farm in a neighbouring state to the one where the person lived. According to WHO, it hasn’t been possible to establish whether this case is related to recent poultry outbreaks.
Flu viruses normally circulate in birds but occasionally can jump to other species, including humans. People catch the viruses from direct contact with infected animals or
contaminated environments. Depending on the original host, type A flu strains can be classified as bird flu, swine flu or other types of animal influenza viruses. Bird flu infections in humans can cause mild to severe upper respiratory tract infections and can be fatal. Eye infections like conjunctivitis, gut symptoms and brain swelling are also possible. (CNN)
About 61% of US adults will have cardiovascular disease by 2050, new research from the American Heart Association predicts. The biggest driver of this trend will be the large number of people who have or will develop high blood pressure, which makes them much more likely to develop dangerous problems like a heart attack or stroke.
Other cardiovascular problems include heart attacks, arrhythmias like atrial fibrillation or a-fib, heart failure and congenital heart disease.
Despite innovations in treatments, heart disease has been the leading killer of Americans for decades, responsible for more than 800,000 deaths every year.
In the research published Tuesday, the association predicts that 45 million adults will have some form of cardiovascular disease – excluding high blood pressure – or will have a stroke in 2050, up from 28 million in 2020. An aging population will be another force behind these trends,

In the research published Tuesday, the association predicts that 45 million adults will have some form of cardiovascular disease
as the older you get, the more likely you are to have heart problems. By 2050, 22% of the US will be over the age of 65, whereas seniors made up just 13% of the population 10 years ago, studies say. The median age in the US is projected
to increase from 37 in 2010 to 41 in 2050, other research shows.
The American population is also becoming more diverse, and communities of colour tend to have a disproportionate number of heart problems. By 2050, people who identify as Hispanic will make up about a quarter of the US population, vs. about 20% today, and people who identify as Black will be 14.4% of the country, up from 13.6% today. The number of people who identify as Asian will
also increase, from 6.2% of the population to 8.6%, according to US Census predictions.
People who identify as Hispanic are projected to have the greatest population growth for cardiovascular disease or stroke, the new research says.
Black adults now have the highest number of heart disease risk factors like high blood pressure, diabetes and obesity, the association’s research shows. They also are projected to have the most problems with poor diet and an inadequate amount of sleep, both behaviours contribute to heart problems.
The biggest overall increase among cardiovascular conditions will be in the number of people who have a stroke, the American Heart Association predicts, jumping from 3.9% to 6.4%. That would nearly double the number of people who have a stroke from 10 million to 20 million adults between 2020 and 2050.
In terms of risk factors, growing
The rate Earth is warming hit an all-time high in 2023 with 92 per cent of last year’s surprising record-shattering heat caused by humans, top scientists calculated.
The group of 57 scientists from around the world used United Nations-approved methods to examine what’s behind last year’s deadly burst of heat. They said even with a faster warming rate they don’t see evidence of significant acceleration in humancaused climate change beyond increased fossil fuel burning.
Last year’s record temperatures were so unusual that scientists have been debating what’s behind the big jump and whether climate change is accelerating or if other factors are in play.
“If you look at this world accelerating or going through a big tipping point, things aren’t doing that,” study lead author Piers Forster, a Leeds University climate scientist, said. “Things are increasing in temperature and getting worse in sort of exactly the way we predicted.”
It’s pretty much explained by the buildup of carbon dioxide from rising fossil fuel use, he and a coauthor said.
Last year the rate of warming hit 0.26 degrees Celsius (0.47 degrees Fahrenheit) per decade — up from 0.25 degrees Celsius (0.45 degrees Fahrenheit) the year before. That’s not a significant difference, though it does make this year’s rate the highest ever, Forster said.
Still, outside scientists said this report highlights an ever more alarming situation.
“Choosing to act on climate has become a political talking point but this report should be a reminder to people that in fact it is fundamentally a choice to save human lives,” said University of Wisconsin climate scientist Andrea

Dutton, who wasn’t part of the international study team. “To me, that is something worth fighting for.”
The team of authors — formed to provide annual scientific updates between the every sevento eight-year major UN scientific assessments — determined last year was 1.43 degrees Celsius warmer than the 1850 to 1900 average with 1.31 degrees of that coming from human activity. The other 8 per cent of the warming is due mostly to El Nino, the natural and temporary warming of the central Pacific that changes weather worldwide and also a freak warming along the Atlantic and just other weather randomness.
On a larger 10-year time frame,
which scientists prefer to single years, the world has warmed about 1.19 degrees Celsius (2.14 degrees Fahrenheit) since pre-industrial times, the report in the journal Earth System Science Data found.
The report also said that as the world keeps using coal, oil and natural gas, Earth is likely to reach the point in 4.5 years that it can no longer avoid crossing the internationally accepted threshold for warming: 1.5 degrees Celsius (2.7 degrees Fahrenheit).
That fits with earlier studies projecting Earth being committed or stuck to at least 1.5 degrees by early 2029 if emission trajectories don’t change. The actual hitting of 1.5 degrees could be years later, but it would be inevitable if all that
carbon is used, Forster said.
It’s not the end of the world or humanity if temperatures blow past the 1.5 limit, but it will be quite bad, scientists said. Past UN studies show massive changes to Earth’s ecosystem are more likely to kick in between 1.5 and 2 degrees Celsius of warming, including eventual loss of the planet’s coral reefs, Arctic sea ice, species of plants and animals — along with nastier extreme weather events that kill people.
Last year’s temperature rise was more than just a little jump. It was especially unusual in September, said study co-author Sonia Seneviratne, head of land-climate dynamics at ETH Zurich, a Swiss university.
The year was within the range of what was predicted, albeit it was at the upper edge of the range, Seneviratne said.
“Acceleration if it were to happen would be even worse, like hitting a global tipping point, it would be probably the worst scenario,” Seneviratne said. “But what is happening is already extremely bad and it is having major impacts already now. We are in the middle of a crisis.”
University of Michigan environment dean Jonathan Overpeck and Berkeley Earth climate scientist Zeke Hausfather, neither of whom were part of the study, said they still see acceleration. Hausfather pointed out the rate of warming is considerably higher than 0.18 degrees Celsius (0.32 Fahrenheit) per decade of warming that it was between 1970 and 2010.
Scientists had theorized a few explanations for the massive jump in September, which Hausfather called “gobsmacking.” Wednesday’s report didn’t find enough warming from other potential causes. The report said the reduction of sulfur pollution from shipping — which had been providing some cooling to the atmosphere — was overwhelmed last year by carbon particles put in the air from Canadian wildfires.
The report also said an undersea volcano that injected massive amounts of heat-trapping water vapor into the atmosphere also spewed cooling particles with both forces pretty much canceling each other out.
Texas Tech climate scientist and chief scientist at the Nature Conservancy Katharine Hayhoe said “the future is in our hands. It’s us — not physics, but humans — who will determine how quickly the world warms and by how much.” (Caribbean Loopnews)
to 60.6%, affecting more than 180 million people by 2050.
numbers of people with obesity and/or diabetes will also raise the risk of heart problems.
Poor diet, which can hurt heart health, is projected to be the health behaviour that will affect the most people. The report suggests that nearly 70 million young adults alone will be eating poorly in 2050.
The new research predicts that the number of people with obesity will increase from 43.1%
The number with diabetes will increase from 16.3% to 26.8% and impact more than 80 million in that period, the report said.
The report also offers a closer look at the heart health of children. It finds “concerning trends” in key risk factors, including a predicted increase in the number of kids living with obesity, in large part due to a lack of exercise and poor diet. The report projects that the number
of US children with obesity will jump from 20.6% in 2020 to 33% in 2050, meaning 26 million kids will have obesity by that time. There’s one positive heart health note, the researchers said: The number of people with high cholesterol is projected to decline. It’s been falling for years, studies show, due in part to the sharp increase in the number of people who take drugs called statins, which can reduce the amount of cholesterol produced in the liver. A 2023 study found
that more than 92 million adults in the US – more than a third of the population – took a statin in 2018-19, a 197% increase from 2008-09.
“Clinical and public health interventions are needed to effectively manage, stem, and even reverse these adverse trends,” the researchers wrote. One significant change they suggest is the creation of clinical and policy interventions specifically to help people of colour, who are already
disproportionally affected by heart problems and who tend to have less access to basic affordable health care.
Prevention efforts to improve population health would also be important, the researchers said, and would save the US a significant amount of money. The costs of cardiovascular problems – including direct health care costs and productivity losses –are expected to almost triple to more than $1.8 trillion by 2050. (CNN)
A major cause of inflammatory bowel disease (IBD) has been discovered by UK scientists.
They found a weak spot in our DNA that is present in 95% of people with the disease.
It makes it much easier for some immune cells to go haywire and drive excessive inflammation in the bowels.
The team have found drugs that already exist seem to reverse the disease in laboratory experiments and are now aiming for human trials.
Crohn’s disease and ulcerative colitis are the most common forms of inflammatory bowel disease. They are estimated to affect half a million people in the UK.
It often starts as a teenager or young adult.
Lauren Golightly, who is now 27, had her first symptoms when she was 16 years old and had stomach cramps and blood in her poo.
But this was put down to partying and it was not until she was 21 and having surgery to remove her appendix that doctors realised she had Crohn’s disease.
Three years ago she needed an emergency stoma after part of her intestines had “shut down” and still has to “take a lot of pain medication” because of the number of operations she has needed.

“It’s not the life I’d aspire to be living,” she says.
SO WHAT IS GOING WRONG?
One part of the immune system that is highly implicated in IBD are white blood cells called macrophages.
These flood the linings of the intestines where they release chemicals – called cytokines – that lead to massive inflammation.
Inflammation is part of the body’s normal response to
Sportswomen make fewer mistakes and have quicker reactions when they are on their period, a study suggests.
Tests designed to mimic the mental processes involved in team sports assessed 241 women’s reaction time, attention, accuracy, and spatial cognition - 14 days apart.
They felt worse when menstruating and thought their performance would suffer - but on average, they were 12% faster at ball-moving tasks and 25% more likely to pass a test of their anticipation skills.
It could explain why women playing contact sports appear injury prone in their luteal phase, between ovulation and menstruation, University College London researchers say.
Lead author Dr Flamina Ronca said the study, conducted with the Institute of Sport, Exercise & Health and published in the journal Neuropsychologia, was “proof of principle” this was linked with fluctuating hormones during the menstrual cycle.
“What we’re seeing is that the the reaction times are a bit slower in the luteal phase and that fits with the fact that we’re seeing a greater incidence of of injuries,” she said.
During the luteal phase, women experience: a drop in oestrogen, which stimulates parts of the brain and increased levels of progesterone, which inhibits cognitive function and can slow reaction times.
These changes begin to reverse during menstruation.
“We wondered if injuries could
the Francis Crick Institute.
The gene controls the suite of inflammatory chemicals the macrophages release, and some people are born with a version that make their body prone to responding excessively.
Dr Lee told me: “This is undoubtedly one of the central pathways that goes wrong for people to get inflammatory bowel disease.
“It is the process by which one of the most important cells that causes inflammatory bowel disease goes wrong.”
WORLD FREE FROM IBD?
The drugs would also need to be precisely calibrated to calm the IBD, but not leave a patient susceptible to infection by switching off the good side of inflammation in fighting disease. They aim is to start clinical trials within five years.
infection, but too much for too long can have devastating health consequences.
The group of researchers at the Francis Crick Institute and University College London performed a deep genetic analysis to try to unpick the cause of the IBD.
They discovered a section of genetic code – or DNA – that turns out to be the macrophage’s “master regulator” of inflammation.
It sits right at “the top of the pyramid” says Dr James Lee, from
Further experiments, detailed in the journal Nature, showed drugs that are already approved for other conditions such as cancer were able to calm this excessive inflammation.
These were performed using samples from patients with IBD.
“We found not only how and why it goes wrong, but potentially a new way of treating these diseases,” says Dr Lee.
Yet, there is not going to be an new IBD treatment imminently.
The researchers have a head start as drugs already exist, but they need to find a way of targeting just the macrophages so they do not cause side effects throughout the body.
“This research is a really exciting step towards the possibility of a world free from Crohn’s and colitis one day,” Ruth Wakeman, from the charity Crohn’s & Colitis UK said. She added: “Crohn’s and colitis are complex, lifelong conditions for which there is no cure, but research like this is helping us to answer some of the big questions about what causes them.”
However, genetic susceptibility is still only half the story. It also takes something to trigger the development of IBD, with diet and antibiotic use all implicated.
SYMPTOMS OF IBD · diarrhoea · stomach pain or cramps · blood in poo · bleeding from your bottom · fatigue · losing weight without trying The disease is distinct from irritable bowel syndrome (or IBS) although some of the symptoms overlap. A diagnosis of IBD is only made if there is inflammation in the bowels. (BBC)

Women were 12% faster at ball-moving tasks and 25% more likely to pass a test of their anticipation skills during their period
be a result of a change in athletes’ timing of movements throughout the cycle,” Dr Ronca told BBC News.
And she hoped the study would mean women playing contact sports could adapt their game plan around their menstrual cycle.
“If I know I might be more likely to to make a mistake in timing and
movement, I might not go for a tackle that day,” Dr Ronca said.
“I might adopt a different strategy in the game.
“It’s just changing the way we play and being aware.”
“Having this awareness and knowing what’s happening with your body, it’s actually quite
comforting to athletes, because at least you have an explanation to why you might be making more mistakes or something might not be quite right.
“And if you know what’s happening, then you can be more more conscious of the decisions that you’re making.” (BBC)
Premier League clubs have voted by 19-1 in favour of keeping video assistant referees (VAR) next season.
Wolves triggered a vote on the use of VAR in the 2024-25 season after formally submitting a resolution to the Premier League in May.
In order for VAR to be scrapped, 14 of the 20 Premier League clubs needed to vote in favour of doing so.
But only Wolves voted in favour of the proposal as they failed to gain any support from other top flight clubs.
Wolves said they were “disappointed with the outcome of the vote” but welcomed the
Premier League’s “commitment to improve VAR”.
The Premier League has come under increasing pressure to modify VAR, which was introduced at the start of the 2019-20 season.
Wolves listed nine reasons to support its proposal to ban VAR, including the impact on goal celebrations, hostility towards match officials and the length of time needed to reach decisions.
It was reaffirmed at the meeting that semi-automated offsides will be introduced at some point in the autumn, while the Premier League confirmed in-game VAR announcements will be put in place.
The in-game announcements,

The United States pulled off one of the biggest shocks in cricket history by beating former champions Pakistan in a super over in Dallas.
Pakistan looked to be avoiding embarrassment at the T20 World Cup before Nitish Kumar hit the final ball of the US innings for four to tie the scores at 159.
Sloppy for large parts of the game, Pakistan fell apart in the added time. Mohammad Amir bowled three wides, one of which the co-hosts also pinched two extra runs from.
The US scrambled to 181, leaving Pakistan to chase 19 off left-arm seamer Saurabh Netravalkar. With 14 needed off four, Kumar made another stunning intervention, this time holding a magnificent catch at long-off to dismiss Iftikhar Ahmed.
With seven required from the last ball, Shadab Khan could only
which were used during the 2023 women’s World Cup, will see referees explain post-VAR decisions to supporters in stadiums.
In addition, the Premier League said the “high threshold” bar for VAR officials to intervene over subjective on-field decisions would be maintained.
Malcolm Clarke, chairman of the Football Supporters’ Association, said “enormous changes” were needed to the current system because fans “cannot carry on like this.”
It is no surprise Wolves’ proposal to get rid of VAR was rejected.
Given the Premier League was committed to paying for it, whether they used it or not, any likelihood of clubs joining Wolves was nonexistent.
However, Wolves’ secondary aim was to generate a wider debate and they have achieved that aim.

No-one, whether it is clubs, match officials or the Premier League, is happy with what is happening at the moment.
The Premier League wants greater transparency, which referees’ chief Howard Webb believes will lead to greater understanding of the decisionmaking process.
Clubs - and players - want better decisions more quickly.
The introduction of semiautomated offsides from next autumn should help achieve that.
League officials are stressing the technology, which has been tested and analysed during the current campaign, will not eliminate delays - but it should provide quicker decisions, particularly on the marginal calls, which seem to take forever at the moment.
The average reduction, it is being claimed, will be 31 seconds.
But there is still work to do. The Premier League needs to avoid finding itself in this position again, otherwise the vote might not be so clear-cut. (BBC)

take a single, sparking joyous celebrations among the American players and supporters.
All this at the end of a riveting contest, one which fluctuated in the burning Texas sunshine.
Pakistan recovered from 263, including an astonishing catch from America’s Steven Taylor, to post 159-7.
The US were cruising in the chase, at one stage needing only 56 runs from seven overs with nine wickets in hand.
Pakistan forced the super over and should have escaped, but the US completed the first upset of this expanded World Cup, one that gives them every chance of reaching the Super Eights.
After beating Canada in their opening game, they may now need only one win in their remaining group matches against India and Ireland in order to qualify.
World Athletics has announced a new global championship to start in 2026 which will feature the biggest prize fund in the sport’s history.
The World Athletics Ultimate Championship will see world champions, Olympic champions, Diamond League winners and the year’s leading athletes go up against each other while representing their national teams.
The event will have a $10m (£7.87m) kitty with gold medallists receiving $150,000 (£118,000).
Competition will take place over three evening sessions and will include
sprints, middle and long-distance races, relays, jumps and throws.
World Athletics says it will be “the ultimate season finale” and will be a “thrilling and fast-moving new format for athletics”.
Budapest, which staged last year’s World Championship, will host the inaugural event from 1113 September 2026 - and it will be held every two years after that with host cities to be decided.
“With only the best of the best on show and cutting straight to semi-finals and finals, we will create an immediate pressure to
perform for athletes,” said World Athletics president Lord Coe.
“The World Athletics Ultimate Championship will be high on action and excitement for fans, setting a new standard for track and field events.
“Featuring athletics’ biggest stars, it will be a must-watch global sports event and means track and field will host a major global championship in every single year, ensuring for the first time that athletics will enjoy a moment of maximum audience reach on an annual basis.” (BBC)
Iga Swiatek continued her dominance over Coco Gauff to reach the French Open final and move closer to a third straight title at Roland Garros.
World number one Swiatek will face Italian 12th seed Jasmine Paolini in Saturday’s final.
Poland’s Swiatek, 23, broke Gauff in the first game of the match and, apart from briefly losing serve in the second set, retained control to win 6-2 6-4.
Third seed Gauff saved three match points before Swiatek closed out victory.
The 20-year-old American has now lost 11 of her 12 matches against the world number one.
“It was intense, especially in the second set but I’m happy,” said Swiatek.
“I stuck with my tactics, didn’t overthink things and just went for it.”
Paolini, 28, beat unseeded 17-year-old Russian Mirra Andreeva 6-3 6-1 in the second semi-final on Thursday.
GAUFF CANNOT END SWIATEK HEX
Whatever happened between Swiatek and Gauff, the pair were still going to leave Roland Garros as the leading two women’s players in the world rankings.
But the outcome again illustrated the gulf between them when they face each other.
US Open champion Gauff talked bullishly after beating three-

time major finalist Ons Jabeur in the quarter-finals, saying she had “nothing to lose” and claimed the pressure was on Swiatek.
That is not how it panned out. Gauff looked overcome by nerves from the start and paid the price.
Trying to land heavily with her forehand in the rallies did not come off, with a stream of errors from that side doing a lot of the work for Swiatek.
Gauff made 18 unforced errors in a first set where Swiatek only needed to hit two winners and the American’s body language showed she was feeling the pressure.
After going for a bathroom break to gather her thoughts, Gauff had to dig deep to hold serve at the start of the second set before a row with umpire Aurelie Tourte over a line call sparked her into life.
An emotional Gauff appeared to wipe away tears between points

in the next game - but the energy fuelled her into breaking Swiatek’s serve for a 3-1 lead.
However, Gauff could not consolidate and, although she showed more resistance towards the end, she has more problemsolving to do about how to end Swiatek’s hex.
The question before the tournament was whether anyone could stop Swiatek becoming only the third woman to win three French Open titles in a row.
She is aiming to join Monica Seles (1990–1992) and Justine Henin (2005–2007) as the only women to achieve the feat in the Open era.
Only former world number Naomi Osaka, who had little previous form on clay and won
Katarina Johnson-Thompson will renew her rivalry with Olympic heptathlon champion Nafi Thiam at the European Athletics Championships in Rome before their anticipated battle for gold at Paris 2024.
Johnson-Thompson, 31, will aim for a first Olympic medal in Paris this summer, 12 months after the Briton was crowned world champion for the second time in Budapest.
Belgium’s Thiam, absent from last year’s World Championships with injury, is seeking a third successive European title - before aiming for another hat-trick at the Olympics following successes in Rio and Tokyo.
“It’s a title I haven’t won, it’s a title I would like to have. But as a heptathlete, I know so much can go right, so much can go wrong, so much can happen,”

Johnson-Thompson told European Athletics., external
“I’m feeling really motivated, probably more motivated than ever coming off the back of last year. Now I just want to put out a good performance.”
Great Britain have named a strong squad which also includes Olympic and world 800m silver
medallist Keely Hodgkinson, world indoor pole vault champion Molly Caudery and former world 200m champion Dina AsherSmith.
Live coverage of the six-day championships from 7-12 June will be shown on BBC Red Button, BBC iPlayer and the BBC Sport website and app.
maiden major singles final with a powerful performance against Andreeva.
The late-blooming Italian’s run at Roland Garros is the latest surprise in a season where she has registered several career milestones.
Paolini had never previously gone beyond the second round in Paris, but has built on lifting the first WTA 1,000 title of her career in Dubai and earning notable wins over some established top-20 players.
her four majors on hard courts, has come close to stopping her.
Swiatek has gone up several gears since that titanic secondround contest - where she saved a match point before winning in three sets.
She did not drop a game in a 40-minute thrashing against Anastasia Potapova in the fourth round and made light work of 2019 finalist Marketa Vondrousova in the quarter-finals.
Paolini is the final player in Swiatek’s way after reaching a
After beating third seed Elena Rybakina in the quarter-finals, she continued to use her powerful forehand to draw mistakes from 38th-ranked Andreeva.
The teenager, who was the youngest Grand Slam semi-finalist since Martina Hingis at the 1997 US Open, was visibly emotional as the second set ran away from her.
“I learned a bit later than other players maybe but to dream is the most important thing in sport and life. I’m happy I could dream this moment,” Paolini, who won the final five games of the match, said. (BBC)

Kenya’s 10km road race world record holder Rhonex Kipruto has been banned for six years because of irregularities found in his Athlete Biological Passport.
The 24-year-old will be stripped of his record, which he set in Valencia in 2020, and the 10,000m bronze medal he won at the 2019 World Championships.
He will be banned until May 2029 after being provisionally suspended on 11 May 2023 for violating anti-doping rules.
An ABP is an electronic record which tracks an athlete’s biomarkers over their career. If these markers change dramatically it alerts officials that the athlete might be doping.
“The Tribunal rejected Kipruto’s defence, concluding the ‘cause for the abnormalities in the ABP is more likely to be due to blood manipulation’ such as through the use of recombinant human erythropoietin (rEPO),” said the Athletics Integrity Unit (AIU), which has enforced the ban.
“There was ‘no other plausible explanation’ for the abnormal values.”
The disciplinary panel said it was “comfortably satisfied” the athlete had committed an AntiDoping Rule Violation (ADRV).
Kipruto can appeal against the decision to the Court of Arbitration for Sport.
Golden Girl Pauline Davis’ awardwinning book “Running Sideways” has gone global.
The book, which portrays her rise from running barefoot out of the grassroot to international acclaim as an Olympic champion, will be translated into Chinese for studies by students in colleges and universities in China, according to Davis and her publicist Jeff Todd.
Todd, who wrote the book, revealed that Davis signed and sealed the deal that was delivered to her on Monday by a Chinese professor who, after reading the script, was intrigued by her journey.
“A Chinese printing press will be translating the book and putting into the hands of hundreds and thousands of Chinese university students and maybe more people in China as well,” Todd revealed. A retired Davis, who is now working as a consultant at the Ministry of Youth, Sports and Culture, said she’s over the moon.
“I am beyond belief. I am scratching my head because I never believed something like this would happen to me,” Davis said. “I just wanted to tell my story.
“I wanted things to be better for my fellow Bahamian athletes and athletes all around the world.

I want them to know that at times you will run through road blocks and speed bumps, but you just have to push through them. You have to run them over.”
When she collaborated with Todd in writing the script, Davis said she never thought in a million years that it would eventually be translated into another language, especially Chinese.
“My mother calls me ‘Sweet P’ because she said I have a good heart. She said my heart always touches people,” Davis said. “She
said ‘baby,’ young have a really good heart.
“I think part of that is because I naturally love people. I want to reach out and help people. I always wanted to help people. My mom said from I was young; I was always like that. That is why she called me “Sweet P.’”
As a result of her nature, Davis said she believe that God has and continue to bless her as she went through the obstacles that she had to endure.
“When I was down, the
Bahamian people were giving me all types of love, so what I did running track and field, I did it for them,” she insisted. “They show me so much love every day I walk the streets. I am so blessed to be a paet of this beautiful country we call The Bahamas.”
For Todd, who has wrote quite a few manuscripts, it’s the first time that any of his publication has international.
“”It’s pretty special to have your book translated into another language,” Todd said. “It’s not something that Pauline or I could have prevented. It’s just been a great ride.
“I’m so happy that we worked together to put this book together. We’ve gone from winning two international awards to printing a second edition to now getting it translated into Chinse, one of the most populace country in the world. It’s amazing. It means a lot.”
So far, more than 10,000 copies of the book have been printed. With this deal in China, the numbers could escalate as they read into her genuine experience.
“I’m really happy for Pauline. I know she’s been waiting a long time for this deal to be done,” Todd said.
Davis said she can’t believe that all these college students in China will be reading her book. he said she is expected to travel to China at some point in the future to promote her book to a wider audience.
“I’m just over the moon,” said Davis as she eager awaits a trip to the Orient where she would have competed at some point during her long and illustrious track career.
The 57-year-old Davis shined from the top regional junior CARIFTA Games as the Austin Sealy award winner in 1984 in Nassau as the most outstanding athlete in prominence at the global World Championships and Olympics, both individually and as a member of the Golden Girls women’s 4 x 100mk relay team. She competed in five Olympics, winning her first medal in 1996 in Atlanta, Georgia with the women’s relay team of Savatheda Fynes, Chandra Sturrup, Debbie Ferguson-McKenzie and Eldece Clarke, and her first gold with the same team at the Sydney, Australia games in 2000.
At those same games in Sydney, after American Marion Jones was banned nine years later for a doping violation, Davis was elated from silver to her first individual gold in the 200m. (Tribune242)
The International Cricket Council (ICC) has promised ground staff will try to “remedy” ongoing problems with the drop-in pitches at its showcase ground in New York.
Cricket’s world governing body publicly acknowledged for the first time since the T20 World Cup began that there have been teething issues with the surfaces.
Players and coaches have so far refused to criticise the pitches at the venue.
However, BBC Sport understands India have privately voiced their unhappiness with the unpredictable bounce and two-paced nature of the strips in Eisenhower Park amid worries over the safety of their batters.
“The ICC recognise that the pitches used so far at the Nassau County International Cricket Stadium have not played as consistently as we would have all wanted,” said a statement from the governing body.
“The world-class grounds team have been working hard since the conclusion of yesterday’s game to remedy the situation and deliver the best possible surfaces for the

remaining matches.”
Concerns have grown over the unpredictable nature of surfaces after the first two fixtures played at the venue.
On Monday, Sri Lanka were bowled out by South Africa for 77 – their lowest score in T20s - while India dismissed Ireland for 96 on Wednesday.
India play Pakistan on Sunday
at the venue in Eisenhower Park in one of the most eagerly-anticipated fixtures of the tournament with a capacity crowd of 32,000 expected.
ICC officials have maintained there are no contingency plans in place to switch any of the New York games to venues in Florida or Texas, both of which have natural turf strips.
The US is staging 16 of the 55
matches at the T20 World Cup, which it is co-hosting with the West Indies.
The pop-up stadium in New York has cost £24m ($32m) to construct and was built inside eight months to much fanfare from the tournament organisers.
Six of the trays which transported the soil for the 10 Tahoma grass surfaces came from
Australia before being shipped to Florida where the pitches were cultivated.
The soil variety has a high clay content, similar to the pitches in Adelaide.
They were then transported to New York by road and installed a few weeks before the tournament began.
The outfield is made up of Kentucky bluegrass, grown at a farm in New Jersey, on top of sand.
There was discontent with the pitch after Monday’s opening match in which South Africa were able to stroll to their victory target against Sri Lanka with 22 deliveries remaining, while India had 46 balls left when they hit the winning runs in another lowscoring match against Ireland.
It has meant the toss in New York has become pivotal in determining the outcome of the match, with the team bowling first at an advantage.
Batters have had to fend off short-pitched bowling, with balls climbing off a length while others skid along at ankle height through to the wicketkeeper.
A clear diagnosis for the problems has not yet been identified.
Malachi Jarrett, a 20-yearold student enrolled in the TCI Sports Commission’s Project IDEA Media Club (PIDEA) has secured numerous film acceptance letters and scholarships, using his PIDEA portfolio according to information from the TCISC.
Since joining the club, his career in media has created a life of its own. After his passion for media began to materialise, he took up a media internship at the Sports Commission, excelling in this department. He has since worked on live streams, photography, and videography at over 30 games, forums, and private events.
While in PIDEA, with guidance from Executive Producer Samuel
Jules and Project Lead Nandina Hislop, he directed and screenwrote the Ripple Effect film which is due to premiere on June 15th.
“His great work on this film has led to him receiving numerous offers to study film at university in the upcoming academic year,” the TCISC stated.
On this accomplishment, Jarrett says, “Project IDEA helps aspiring students to hone in on their filmmaking and media skills, creating an environment for bright futures as it did for me. I am happy to embark on the new journey ahead of me, as I progress in my filmmaking and media studies courses at a university of my choice. This can pave the way for not only my country but for the people that look up to me.”
The Sports Commission noted that Malachi is one of over 20 students who have benefited from this programme, which continues to be productive in expanding the TCI sport media pool.
“Support the Project IDEA Media Club by attending the Igniting Change: Transforming Lives through sports event on June 15th! Here we will feature the world premiere of the local short film, ‘Ripple Effect’, hosting a night to remember.”
To reserve a table, purchase a ticket, or receive further information, please email Calvina Andrews at candrews@gov.tc.
For more information on the event please go to: https://www. gov.tc/.../our-events/project-i-d-ea-media-club.


Malachi Jarrett

According to information from the TCICA, the “aim of the travel was to visit major facilities, with priorities being pool facilities, and to discuss sport development strategies”
The Turks and Caicos Islands Sports Commission (TCICA) recently travelled to the Cayman Islands and Barbados to assess their sporting facilities and discuss key strategies with the islands’ sporting officials.
According to information from the TCICA, the “aim of the travel was to visit major facilities, with priorities being pool facilities, and to discuss sport development strategies”.
The local delegation was led by the Director of Sports, Mr Jarrett Forbes, Deputy Director, Mr Alvin Parker and Facility Manager for Providenciales, Mr Darian Forbes.
The team was hosted by the
Deputy Chief Officer for Sports, Dr Dalton Walter, and the Director of Sports, Mr Kurt Hyde in the Cayman Islands; who facilitated the facilities tour and shared valuable information on sport development.
Meetings were held with Deputy Chief Officer, Ms Joan West and Technical Director for the Cayman Islands Aquatics Sport Association, Mr Jacky Pellerin, on the Cayman Islands’ new 50-metre and 25 metre 10-lane Mrytha pool facility, as well as with Ms Shakeina Bush from the National Olympic Office on national federation development and funding opportunities.
The Sports Commission
delegation was also grateful for the courtesy call with the Minister of Sport for the Cayman Islands, Hon Isaac Rankine, and the Chief Officer Ms Teresa Echenique.
During the Barbados leg of the exploratory travel, the Sports Commission team was hosted by the Director of the National Sports Council, Mr Neil Murrell, and the Assistant Director of Sports, Mr Ryan Toppin.
The TCI team toured the National Sport Council facilities and visited the Barbados National Olympic Association.
Significant to the TCI’s plan to develop an aquatic centre, the TCI
Sports Commission visited the Barbados Aquatic Sport Association and met with former National Olympic Academy Director, Mr Dave Farmer, and the President and Second Vice President of the Barbados Swim Association, Mr Robert Armstrong and Mr Nicholas Mathis.
Insights were shared regarding swimming pool design, development and maintenance as well as pool programming strategies to ensure the growth and sustainability of swimming in the islands.
The TCI delegation also visited other stadium facilities such as track and field, football and
cricket, and other major facilities in basketball and boxing.
The Sports Commission release added that the TCI officials had “great discussions with both the Cayman Islands and Barbados sports officials surrounding the development of coaches, athlete development pathways, and strengthening relationships with National Sport Governing Bodies”.
Mr Forbes, said, “We were very grateful for the hospitality and support extended by our Caribbean colleagues. Their support affirmed the commitment and unity among the Caribbean community to develop sports in the region.”



Final preparations are underway for the 14th annual Turks & Caicos Islands “Race for the Conch” EcoSeaSwim set for Saturday, June 29, 2024.
TCI star swimmer, Tajhari Williams, will be back to defend his back-to-back first-place finishes in the 2.4-mile and 1-mile events from last year. He will be contending with several upand-coming TCI swimmers also racing for a conch trophy to take home along with many talented swimmers from abroad.
The beach in front of Rickie’s Flamingo Cafe will once again be the venue for the start and the finish. Swimmers will have a choice of three main distances: 2.4 mile, 1 mile, and 1/2 mile in the
beautiful turquoise waters of Grace Bay. A 100-metre Children’s Swim for youngsters 10-and-under will also be offered.
Race founders/directors, Ben Stubenberg and Chloe Zimmermann, said that they anticipate at least 100 swimmers from overseas, mainly the US and Canada, as well as around 40 local swimmers.
“Last year’s event really showed once more that TCI swimmers can compete and win against top American, Canadian and UK swimmers who fly in for the race,” said Stubenberg. Zimmermann added, “It’s truly inspiring to see how far TCI has progressed in open water swimming right here in their home waters”.
The “Race for the Conch,” rated as one of the top 100 open water races in the world by the World Open Water Swimming Association, has become the biggest international sports event in the Turks & Caicos.
In keeping with the tradition of buying local, race organisers have collaborated with the following local artists: Stanford Handfield to carve conch medals for each participant; Lucie Stubbs to make the plaques that also use conch shells carved by Handfield; Alizee Zimmermann to design the logo and design the race t-shirts.
In addition, locally created “Proud of My Island” will be the official goodie bags for racers. The organisers take seriously the “Eco-
SeaSwim” part of the event name by, among other things, banning sunscreens that are not reef-safe.
At the venue, all swimmers will have free access to the official race sunscreen, Caribbean Sol, which is purely mineral-based. Race for the Conch is a registered TCI nonprofit organisation. Proceeds go to Provo Children’s Home, Reef Fund, TCI Red Cross, and Project Inclusion Turks & Caicos.
The organisers noted that this event could not take place without dedicated volunteers along with generous sponsors, and providers. They include: Grace Bay Club, Ocean Club East, Hartling Group, Experience Turks & Caicos, Whole Health, Caribbean Bottling Company, Atlantic Aviation,
Projetech, Finishing Touch, SurfSide Ocean Academy, Jafooe Computer Services, Silver Palm Charters, DJ Dayoh, Got-UCovered, TCI Red Cross, Big Blue Collective, Paradise Photography, Luxury Experiences Turks & Caicos, Business Solutions, LMNT Electrolytes, Natural Trade Distribution, Caicu Naniki Vacation Adventures, and Marco Travel.
More information about the race, including start times and course description, can be found on the race website www.ecoseaswim.com.
Note that the organisers are offering special discounts for TCI residents. They should register through their swim clubs or at the check-in desk on race day 1.5 hours before the event’s starting time.
